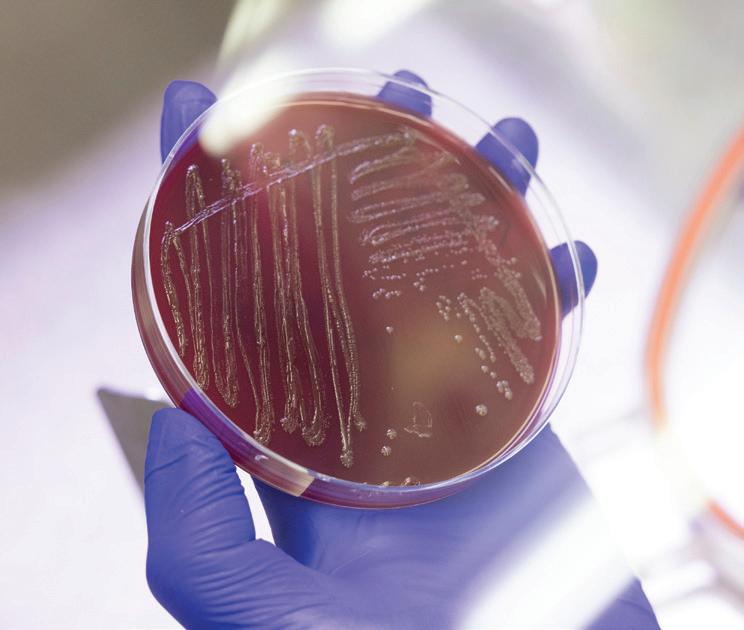

PDMJ
PENN DENTAL MEDICINE JOURNAL | SPRING 2025

BUILDING GUIDANCE FOR BETTER HEALTH
PENN DENTAL COLLABORATING ON ADA LIVING GUIDELINE PROGRAM, ACCELERATING THE TRANSLATION OF RESEARCH INTO CHAIRSIDE CARE, PUBLIC HEALTH PRACTICE

PENN DENTAL MEDICINE JOURNAL | SPRING 2025

PENN DENTAL COLLABORATING ON ADA LIVING GUIDELINE PROGRAM, ACCELERATING THE TRANSLATION OF RESEARCH INTO CHAIRSIDE CARE, PUBLIC HEALTH PRACTICE
IT IS SPRING, and the flowers are blooming and the days are getting longer. It must be time to celebrate a new class of Penn Dental Medicine graduates, entering the profession of dentistry! It is always a great pleasure to celebrate our graduates moving on to the next phase of their education and dental careers. I extend my heartfelt congratulations to the entire Class of 2025 and their families. I look forward to all that this class of stellar graduates will bring to the health profession as they join our accomplished alumni community.
As we recognize this milestone with our graduates, it is a reminder and testament to the School’s legacy in dental education, research, and patient care, and now more than ever, we remain steadfast to advancing our mission. Without a doubt, these are challenging times for higher education and academic research given the uncertain federal funding landscape, but we know that Penn Dental Medicine will thrive going forward. Although the full impact to our operational budget is still unfolding, we are implementing measures throughout the School to reduce expenditures. Therefore, we decided to publish this issue of the Penn Dental Medicine Journal in digital format only (be sure to complete the survey on the PDMJ, see page 39).
In this issue, the strength and depth of our research enterprise is indeed on display. The methodological and technical expertise of our Center for Integrative & Global Oral Health has led to a pioneering collaboration with the American Dental Association (ADA) on the new ADA Living Guideline Program. This recently launched program promises to help accelerate the translation of oral health research into chairside patient care and public health initiatives (see page 10). While in her lab, Dr. Flavia Teles is taking

a microbiologist’s lens to oral health, uncovering the relationship between the microbes that live in the mouth, the immune responses they elicit, and the diseases that afflict oral health and beyond (see page 20). And a look back at 2024 research and scholarship, highlights some of our faculty’s high impact publications as well as new grant awards (see page 14).
Academically, our five advanced graduate degree programs, including the three innovative master’s degree programs we’ve introduced over the past four years, are enabling students to enhance their knowledge and research skills across dental and health-science related fields — three of which provide dual-degree options (see page 28).
As always, I encourage you to take advantage of our continuing education programming (see page 9) and hope you will plan a visit back to Penn Dental Medicine soon.
Stay well and stay connected,




The School’s Center for Integrative Global Oral Health collaborating on new ADA Living Guideline Program
Flavia Teles, DDS, MS, DMSc, is taking a microbiologist’s lens to oral health
Perspective Views on the Educational Experience
Notes News from Fellow Alumni
Memoriam
Members of the Penn Dental Medicine Community
Events & Programs
Building opportunities for dual degrees, research, academic careers, remote learning, and more
PENN DENTAL MEDICINE JOURNAL: Vol. 21, No. 2 University of Pennsylvania School of Dental Medicine www.dental.upenn.edu
Dean: Mark S. Wolff, DDS, PhD
Vice Dean of Institutional Advancement: Elizabeth Ketterlinus
Associate Dean for Leadership Giving: Maren Gaughan
Director, Publications: Beth Adams
Contributing Writers: Beth Adams, Laura Dattaro, Debbie Goldberg, Judy Hill, Photography: Mark Garvin, Lisa Godfrey Office of Institutional Advancement: 215-898-8951
Penn Dental Medicine Journal is published twice a year by the Office of Communications for the alumni and friends of the University of Pennsylvania School of Dental Medicine. ©2025 by the Trustees of the University of Pennsylvania. All rights reserved. The views expressed in this publication are not necessarily those of Penn Dental Medicine. We would like to get your feedback — address all correspondence to: Beth Adams, Director of Publications, Robert Schattner Center, University of Pennsylvania School of Dental Medicine, 240 South 40th Street, Philadelphia, PA 19104–6030, adamsnb@upenn.edu
SCHOOL NEWS IN BRIEF

Penn Dental Medicine is continuing to expand its global connections with other universities through international Memorandum of Understanding (MOU) agreements. These selective partnerships are designed to encourage collaboration and exchange in the areas of research and scholarship, dental education, and clinical practice and training.
“Through these strategic partnerships, we are looking at how we can support each other to strengthen oral healthcare globally and reach shared goals,” says Dr. Bruce Brandolin, Assistant Dean of Intramural Practice and External Partnerships.
Since fall 2024, six new and two renewal MOU agreements were signed. The new MOUs are with University of Ibadan Faculty of Dentistry, Nigeria; University of Regensburg, Germany;
European University-Cyprus, Cyprus; Yeditepe University, Turkey; University of Guyana, Guyana; and Tel Aviv University, Israel. The latest renewal agreements are with Warsaw University Faculty of Medicine and Dentistry, Poland, and Jagiellonian University Medical College, Poland. With these latest additions, Penn Dental Medicine now has 54 international MOUs, enabling faculty and student exchange as well as collaboration on academic, research, and clinical care programs.

By the Numbers 2024: A Year in Review
$20.4M
RESEARCH FUNDING SPENT IN FY24
48,321
PATIENTS SERVED IN 2024 WITHIN THE SCHOOL’S CARE CENTERS & PENN DENTAL FAMILY PRACTICE
7,847
LIVE WEBINAR AND SELF-PACED LEARNERS AT 268 CDE PROGRAMS IN 2024
Achievement
2
YEARS IN A ROW, THE GRADUATING CLASS (CLASS OF 2024 & 2025) HAD A COLLECTIVE SCORE ON THE INTEGRATED NATIONAL BOARD DENTAL EXAMINATION
1.2 STANDARD DEVIATIONS ABOVE THE NATIONAL MEAN

Penn Dental Medicine is adding to its clinical care facilities with plans moving forward for a new general anesthesia/sedation suite, greatly enhancing the School’s ability to deliver oral healthcare to individuals with complex needs.
“The creation of this sedation suite is a next step to build upon the comprehensive care we provide at Penn Dental Medicine,” says Penn Dental Medicine’s Morton Amsterdam Dean, Dr. Mark S. Wolff. “For example, while the behavioral management and stabilization techniques we use in our Care Center for Persons with Disabilities dramatically reduces the need for general anesthesia/sedation among this patient population, some individuals still require sedation due to complex health/ behavior concerns.”
With the addition of the sedation suite, those patients will be able to conveniently receive care at the School, eliminating the often-challenging process of securing time in the operating room of a hospital. “It can be extremely frustrating for families, as long waits are the norm in scheduling appointments in a
hospital setting,” adds Dean Wolff. “Our suite will allow us to further reduce barriers to the specialized care that some patients require.”
In addition to serving persons with disabilities, the facility will also be available to treat the wider community of patients who come to the School and may require general anesthesia for care, including emergency cases or individuals with complex medical conditions or undergoing advanced prosthodontic treatment or other procedures.
The suite will be adjoining the Department of Oral & Maxillofacial Surgery and reclaim first-floor space within the School’s Robert Schattner Center at the corner of 40th and Locust streets, which has been a retail coffee shop. The project will involve some reconfiguring of the existing 2,300-square-foot Oral Surgery Department in the Schattner Center to
“Our suite will allow us to further reduce barriers to the specialized care that some patients require.”
— DR. MARK S. WOLFF
open into the commercially leased footprint of the coffee shop, creating one care center of approximately 5,000 square feet. The facility will feature two operating suites, three pre-/post-procedure rooms, a prep room, two resident touchdown spaces, a nurses station, a nourishment station, instrument management, and storage. Construction is anticipated to be completed within 2026.
To learn more about the project and ways to support it, contact Maren Gaughan, Associate Dean for Leadership Giving, gaughan@upenn.edu.

Four Penn Dental Medicine students have been named 2025 Delta Dental Community Scholars, each receiving a sizeable scholarship in recognition of their community service, academic achievement, and their future plans to work with vulnerable populations after graduation.
Awarded annually to fourth-year students, the scholarship program was established in 2019 through a $1 million grant from the Delta Dental Community Care Foundation, the philanthropic arm of Delta Dental of California and affiliates (Delta Dental), which includes Delta Dental of Pennsylvania. Since its inception, the program has awarded scholarships to more than 20 Penn Dental Medicine students who have expressed a commitment to helping expand access to oral healthcare for hard-to-reach populations.
This year’s recipients — Hind Aljarahi (D’25), Kendra Domotor (D’25), Kaylyn Hudson (D’25), and Allie Schroeder (D’25) — all demonstrate a passion for serving the underserved.
Hind Aljarahi is a National Health Service Corps scholar who has also pursued honors programs in community oral health and vulnerable populations, working at Philadelphia FIGHT Pediatrics and Adolescent Health Center, a federally qualified health center, and caring for refugees and survivors of torture and intimate-partner violence within the School’s Vulnerable Populations Clinic. She also served as co-President of the Community Oral Health Club, which organizes community outreach events and educational programs for underserved communities in Philadelphia. After graduation, she will be entering the advanced dental education program in pediatrics
“Looking ahead, I aspire to continue serving my community as a public health dentist.”
— ALLIE SCHROEDER (D'25)
at Penn Dental Medicine/The Children’s Hospital of Philadelphia and plans to continue working with vulnerable populations after that.
Kendra Domotor, a Master of Bioethics and DMD dual-degree candidate, is the Vice President of the Class of 2025 and a National Health Service Corps Scholar. As a 2022 intern and 2023 dental mentor for the Bridging the Gaps Community Health Internship Program, Domotor worked with local families at Smith Memorial Playground, distributed thousands of oral hygiene products for use throughout Pennsylvania and New Jersey, and taught healthcare graduate students from all fields the tenants of oral health and hygiene. She has also been a community oral health honors student from 2023–2025, rotating weekly at Philadelphia FIGHT, serving an often medically complex population. She will begin a residency at Children’s Hospital of Colorado in Aurora, Colorado after graduation.
At Penn Dental Medicine, Kaylyn Hudson has pursued opportunities to bring awareness and dental treatment to persons with disabilities. In her first summer at Penn, she participated in the Bridging the Gaps Community Health Internship Program, working at HMS School for Children with Cerebral Palsy. As President of Penn Dental Medicine’s chapter of the American Academy of Developmental Medicine and Dentistry (2023–current), and Penn Dental Pediatric Dental Association (2024–current),
she has focused on creating opportunities for students to engage with patients with special healthcare needs. In Fall 2024, Hudson represented Penn at the International Association for Disability and Oral Health in Seoul Korea. After graduation, she will be beginning a residency at Children’s Hospital of Colorado in Aurora, Colorado.
Allie Schroeder is a National Health Service Corps scholar who is also completing a Master of Public Health dual degree. In addition to working extensively with medically underserved populations, she has been a passionate advocate for oral health policy reform, lobbying at both the state and national levels for expanding Medicaid benefits and improving access to oral health services. Focused on improving care for vulnerable populations, Schroeder led a research project on the oral health practices and purchasing behaviors of Medicaid beneficiaries, with the goal of informing oral health policies. “Looking ahead, I aspire to continue serving my community as a public health dentist,” says Schroeder.
Along with this scholarship program, the Delta Dental Community Care Foundation has helped to advance other educational and clinical care initiatives at Penn Dental Medicine, including support to enhance oral care for seniors and for the PennSmiles mobile community care program. “We are proud to stand with Penn Dental Medicine to make a lasting impact in our communities and beyond,” says Kenzie Ferguson, vice president of foundation and corporate social responsibility for Delta Dental.
Hind Aljarahi and Kendra Domotor are also among the 2024-2025 recipients of an ADEA/Haleon Preventative Dentistry Scholarship. These scholarships are awarded annually to 12 students from dental schools within the U.S. and Canada who have demonstrated academic excellence in preventive dentistry.
Penn Dental Medicine DMD student Michael Troka (D’26) has been recognized for the excellence and impact of his research as the recipient of the 2024 ADA Foundation Crest and Oral-B Promising Researcher Award. This highly competitive award honors outstanding contributions to oral health research and the potential for advancing the field through innovative work.
Troka received the award for the project titled “TrokaChatML: A benchtop to clinic machine learning pipeline for disease mechanism deconvolution and drug target discovery.”
Troka, a basic and translational research honors student, has been working in the lab of Penn Dental Medicine’s Dr. Dana Graves, Professor, Department of Periodontics, since he was a Penn undergrad. He first designed TrokaChatML, a unique machine learning platform, as a first-year DMD student when working on a project with Graves.
TrokaChatML machinelearning platform, analyzes cell-to-cell communication disrupted in disease states.
“We wanted to see how different immune cell types were signaling to each other, but no existing tool did exactly what we were looking for,” recalls Troka. “This is what led me to design a new tool from the ground up.” (They called the program TrokaChat in recognition of his efforts)
“The aim of this machine learning platform is to elucidate the complex mechanisms of disease by analyzing intricate patterns of cell-to-cell communication that are disrupted in disease states,” explains Troka. He notes that these disruptions can lead to detrimental physiological changes, thereby highlighting critical intervention points for therapeutic strategies aimed at either mitigating or preventing disease. This bioinformatic

software is specifically designed to leverage single-cell RNA sequencing data to identify disturbances in cell signaling that characterize specific diseases, including oral inflammatory conditions like periodontitis, as well as other diseases, ranging from diabetic complications to cancer.
TrokaChatML uses a sophisticated integration of machine learning with statistical techniques to simplify complex data structures into simpler components, making it easier to analyze and interpret the data. The output prioritizes key cellular interactions that drive disease processes, which provides insights into potential therapeutic targets.
“Michael’s TrokaChatML is an exceptional tool. Unlike traditional drug discovery methods, which often rely on extensive trialand-error, its automated pipeline enhances the efficiency of target selection to significantly enhance the discovery process,” says Graves. “It’s distinguished by the ability to rank the likelihood of key interactions with high precision.”
The use of TrokaChatML has already led to possible therapeutic discoveries. In studies related to atopic dermatitis, for example, it has suggested treatment options currently undergoing clinical trials and identified new targets for early intervention.

In January of this year, Penn Dental Medicine announced the establishment of the Division of Prosthodontics within the School’s Department of Preventive & Restorative Sciences. Dr. Nupur Patel, who joined Penn Dental Medicine in March 2024 as the Director of the Advanced Education Program in Prosthodontics, is the inaugural Division Chief, overseeing the educational, clinical, and administrative functions.
“With the ongoing growth of our instruction and clinical care in prosthodontics, the timing was right to make it a formal division within the Department,” says Dr. Markus Blatz, Professor and Chair of the Department of Preventive & Restorative Sciences.
Penn Dental Medicine launched its Advanced Education Program in Prosthodontics in 2007, and also has a dual certificate program in Prosthodontics and Periodontics that enables graduates to attain board eligibility in both specialties.
With this restructuring, the School’s Department of Preventive & Restorative Sciences now has four divisions – the Division of Prosthodontics, the Division of Restorative Dentistry, the Division of Pediatric Dentistry, and the Division of Community Oral Health. Dr. David Hershkowitz, Associate Professor of Clinical Dentistry and Chief of the Division of Restorative Dentistry, has been promoted to Associate Chair of the Department to Preventive & Restorative Sciences to oversee the divisions under the chairmanship of Dr. Markus B. Blatz.
Two Penn Dental Medicine faculty members – Dr. Alonso Carrasco-Labra, Associate Professor within the Center for Integrative Global Oral Health (CIGOH), and Director of the Cochrane Oral Health Collaborating Center, and Dr. Flavia Teles, Associate Professor in the Department of Basic & Translational Sciences and core member of the Center for Innovation & Precision Dentistry (CiPD) — were among the panel of experts convened by the National Academies of Sciences, Engineering, and Medicine (NASEM) for a public workshop exploring innovative practices and models for advancing oral health in the U.S. across the lifespan.
The NASEM defined the vision for Advancing Oral Health Across the Lifespan was to create a future where every American, regardless of background or circumstances, has equitable access to comprehensive oral healthcare across their lifetime—empowered by a deep understanding of oral health’s impact on overall well-being and supported by inclusive policies, a diverse and accessible workforce, integrated care models, affordable services, lifelong health education, and strong community advocacy. The program was designed to build on prior national initiatives, including the Surgeon General’s report on Oral Health, the National Institute of Health’s report on Advances and Challenges of Oral Health in America, along with NASEM efforts, with the goal of refining strategies and discussing potential milestones to achieve this vision.
Carrasco-Labra and Teles were part of the session titled Enhancing Oral Health Research and Innovation: A Window into the Future — one of the two-day workshop’s 11 sessions.
Teles represented the work of the CiPD, the cross-disciplinary initiative between Penn Dental Medicine and Penn Engineering. The CiPD is uniting dental medicine and engineering to support research, training, and entrepreneurship that spurs oral healthcare innovations and addresses unmet oral health needs. Along with spotlighting the CiPD’s NIH/ NIDCR-sponsored training program and the industry-sponsored fellowships at the Center, Teles also presented on one of her research projects, “Advancing Periodontal Care: Harnessing AI and Comprehensive Patient Data for the Prediction of Disease Progression,” exemplary of the work of the CiPD.
Carrasco-Labra spoke on the important role of evidence-informed clinical and public health guidelines in oral health.
“Guidelines allow efficient translation of research evidence into practice and should be conceived as implementation tools,” says Carrasco-Labra. “Guidelines are the cornerstone of evidence-informed clinical and public health practice. Oral health practice guidelines conducted with rigorous methods and standards, as the ones used in the medical field, will facilitate the coordination and intersection of medical and oral health services (see related story, p. 10).”

Penn Dental Medicine’s Dr. Dana Graves, Professor of Periodontics, Vice Dean for Research & Scholarship and Interim Chair of the Department of Periodontics, has been recognized for his leadership and commitment to the advancement of dentistry as the 2025 recipient of the Alan J. Davis Award/SCADA Achievement Award. Named in honor of the first SCADA Corresponding Secretary, the Award, presented by Dentsply Sirona, is given annually to a clinician for outstanding service to the dental profession or to SCADA (Student Competition for Advancing Dental Research); this is the 59th year the award was presented.

Through a key area of investigation in his own research, Graves has helped to unravel the cellular mechanism through which diabetes affects periodontal disease, bone and wound healing, identifying key mechanisms that may be used to develop treatments for the consequences of this disease. As Vice Dean for Research & Scholarship at Penn Dental Medicine, he works with faculty and students to build the School’s research enterprise across disciplines. Graves has mentored a wide range of students in their research activities and directs the School’s Doctor of Science in Dentistry program.
The award was presented at the AADOCR/CADR Annual Meeting & Exhibition, held March 12-15, 2025, in New York, NY.


Two members of the Penn Dental Medicine faculty — Dr. Miriam R. Robbins and Dr. Hyeran Helen Jeon — have been honored by the Pennsylvania Dental Association (PDA). Robbins received the 2025 PDA Public Service Award and Jeon the 2025 PDA Recognition Award.
“Drs. Robbins and Jeon are so deserving of these awards,” says Penn Dental Medicine’s Morton Amsterdam Dean, Dr. Mark S. Wolff. “They both represent an extraordinary commitment to improving oral health through education, research, and patient care.”
The PDA Public Service Award recognizes individuals whose activities and contributions have improved the oral health of the public, including the underserved and special needs population. As Director of Penn Dental Medicine’s Care Center for Persons with Disabilities, Robbins, Professor of Clinical Oral Medicine and Clinical Restorative Dentistry, plays a leadership role in clinical instruction and patient care for persons with disabilities. Under her leadership, the Care Center for Persons with Disabilities has grown to serve approximately 6,500 patients annually. She is a Diplomate of American Board of Special Care Dentistry, a Diplomate (honorary) and Fellow of the American Academy of Oral Medicine, and Fellow of the College of Physicians of Philadelphia.
The PDA Recognition Award recognizes contributions in education and clinical research that have materially aided and advanced the science and art of dentistry. A clinician scientist, Jeon, Assistant Professor of Orthodontics, joined the Penn Dental Medicine faculty in 2016 after earning her Doctor of Science in Dentistry at the School as well as a certificate in orthodontics (2014). Her main research interests are bone remodeling, wound healing, and maxillary expansion using temporary anchorage devices, and she is an active research mentor to both postdoctoral and predoctoral students.

Foreign-trained dentist Katherine Bencosme (D’25) has embraced the challenges of preparing to practice in the U.S.
While attending high school in the Dominican Republic, Katherine Bencosme (D’25) had already set her sights on studying and practicing dentistry in the U.S. That idea didn’t sit well with her mother, who wanted her daughter to stay close to home. “Once you get your degree here, you can do as you please,” Bencosme remembers her saying.
She abided by her mother’s wishes, but on graduating with a dental degree from the Dominican Republic, Bencosme moved to Miami in 2018 to begin her path to dental practice in the U.S. Working as a dental hygienist in Miami, she began the process of applying to U.S. dental schools, including Penn. Bencosme arrived on campus in January of 2023 as part of the School’s two-and-a-half-year Program for Advanced Standing Students (PASS), which awards non-U.S. trained dentists a DMD, enabling them to take licensing exams in any state. PASS students join the School’s second-year DMD class in January and are then fully integrated into the class for the final two years.
Starting a program at a point where “basically everybody already knows each other” was challenging at first, says Bencosme, and “it did take a minute to get used to
everything that was being thrown at me, but with a little time and organization, I found I could manage things fairly easily.”
And while there were days when she was impatient to be done with her long journey in dental education, ultimately, she says she is glad to have pursued training here. “I’ve learned a lot,” she says. “Dentistry is different in this country, and I feel like we do really need this extra education — every day I learn a little bit more. Plus, here at Penn we have truly amazing faculty.”
In particular, Bencosme says her time at Penn Dental Medicine has deepened her knowledge of endodontics, periodontics, and restorative dentistry, and she has been excited to learn about new techniques and evidence-based approaches to treatment. “I feel what I am learning here is a valuable complement to the education I had in the Dominican Republic,” she says.
Fully immersing herself in her new environment, Bencosme is the elected representative of the PASS class of 2025 to serve on Penn Dental Medicine’s Student Council. She has also been a dental school representative for Penn’s Graduate and Professional Students Assembly (GAPSA) for the past two years. She finds her GAPSA role rewarding because it connects her to the University as a whole and gives her insight into issues important to all 12 graduate schools at Penn.
Within the dental school, she and her fellow Student Council members meet monthly to address students’ concerns and look for solutions. “We’re trying to give a voice to the students for whatever issues they might have — whether it’s around clinics or lectures or scheduling — and to make them feel they are heard.” She has also served as PASS student representative for the school’s Hispanic Student Dental Association and is currently secretary of the executive board of the Hispanic Dental Association’s Pennsylvania chapter.
Bencosme, who says she used to be “somebody who would not come forward easily to speak up,” admits she had to push herself to come out of her shell but says the extracurricular activities have enhanced her educational experience.
After graduating in May, Bencosme will begin a one-year general practice residency with the Veterans Administration in Philadelphia. There, she is looking forward to the opportunity to perform more complex procedures, such as implants and molar endodontic treatments. “I’ll get to do a lot of procedures that go beyond what we’ve done in dental school,” she says. “It’s the cherry on top.”
Long-term, Bencosme is drawn to the field of periodontics. During her earlier dental training in the Dominican Republic, she had gained experience with simple surgery techniques and found that she took to it naturally. She is particularly interested in periodontic surgery and hopes to follow up her GPR with a periodontic residency. She also sees the appeal of exploring her options in general practice in the Philadelphia area.
“The VA is an amazing opportunity, and I feel like I’m going to learn a lot there,” she says. “I am eager to keep pushing forward.”
Save the date for two upcoming continuing education programs — the first at the end of May with a focus on innovation in dentistry, and in July, the return of the biennial Penn Periodontics Conference, providing a forum to exchange the latest research in the field of periodontics.
May 29, 2025 at Penn Dental Medicine
The CiPD, the joint center between Penn Dental Medicine and Penn Engineering, will present its annual symposium — Dentists, Scientists, and Engineers Transforming Oral Health. This all-day event will feature a fireside chat with Nobel Laureate Drew Weissman (Penn Medicine) and plenary talks by Joseph DeSimone (Stanford School of Medicine) and Edward Zuckerberg (Painless Social Media, CEO). In addition, CiPD faculty, trainees, and fellows will share their cutting-edge research on emerging applications — from craniofacial and tissue regeneration to oral microbiomes — using advanced materials, nano/biotechnology, mRNA, AI, and robotics. Join us to explore how innovation and entrepreneurship are shaping the future of oral and craniofacial healthcare.
Learn more and register at www.dental.upenn.edu/CiPDSymp
July 28 – August 1, 2025 at Penn Dental Medicine
The 7th Penn Periodontal Conference will continue the celebration of the 70th anniversary year of Penn Dental Medicine’s Department of Periodontics. This biennial event brings together leading researchers, educators, and junior investigators to exchange the latest advancements in periodontics. Featuring keynote speakers John Seykora, MD, PhD (Penn Medicine) and Pamela Robey, PhD (NIH), the program will explore topics such as periodontal disease mechanisms, host-microbe interactions, bioengineering, and new treatment modalities. With interactive sessions and a poster presentation, the conference fosters collaboration and innovation in the field.
Learn more and register at www.dental.upenn.edu/pennperio2025

Five years ago, as the COVID-19 pandemic shuttered operations for most across the country and around the globe, Penn Dental Medicine continuing dental education (CDE) pivoted to online programming to ensure ongoing learning and engagement for alumni and other clinicians. That change led to the development of a robust offering of online lectures across disciplines that has continued to grow and evolve, and while in-person CDE programming has returned, the online CDE Portal that was developed enables a wide variety of online learning to continue, featuring both live streaming and on demand lectures (access the portal at www.cde.dental.upenn.edu).
Managing the organization and execution of the growing and evolving CDE program is the School’s CDE team that includes Pamela Rice, Senior Director of Continuing Education (center), Rachel Dager, Associate Director of Continuing Education (left); and Brittani Kelly, Continuing Education Program Coordinator (right).
Here is a recap of the CDE program by the numbers over the past five years.
542
LIVE PROGRAMS
75,228
LEARNERS
140+
COUNTRIES REPRESENTED
View CDE programming at www.dental.upenn.edu/CDE



“The artificial intelligence (AI) technology supporting the living guideline program maps all available biomedical databases, looking for evidence on a daily basis. ”
— OLIVIA URQUHART
THE SCHOOL’S CENTER FOR INTEGRATIVE GLOBAL ORAL HEALTH
Oral healthcare providers and patients will soon have more frequent, evidence-informed recommendations to help guide care and improve health outcomes through the recently launched ADA Living Guideline Program — a pioneering collaboration between Penn Dental Medicine’s Center for Integrative Global Oral Health (CIGOH) and the American Dental Association (ADA). It is the first and only known living guidelines program dedicated to oral health and promises to accelerate the translation of oral health research into chairside patient care and public health initiatives.
“We are proud to be part of bringing this important service to our profession and look forward to helping improve patients’ oral health through this guidance,” says Penn Dental Medicine’s Morton Amsterdam Dean, Dr. Mark S. Wolff.
We sat down with the CIGOH faculty leading the program at Penn Dental Medicine — Dr. Alonso Carrasco-Labra, Director of the Cochrane Oral Health Collaborating Center at Penn Dental Medicine and Associate Professor in the Department of Preventive & Restorative Sciences; Olivia Urquhart, CIGOH guideline methodologist and instructor in the Department of Preventive & Restorative Sciences; and Dr. Michael Glick, Executive Director of CIGOH — to learn more about it.
“The guidelines program fits into the way CIGOH was envisioned from the beginning. Part of our mission and vision is to support clinicians and public health practitioners.”
— DR. MICHAEL GLICK


This is a very different process from how oral health practice guidelines were developed in the past. First, we are implementing a living guideline model, which means we will be continuously monitoring the literature for new evidence and data that can affect the guideline recommendations and dynamically updating them as needed. So, that results in guideline recommendations that are more relevant to the problems in front of clinicians at the very moment. Traditionally, guidelines have been updated every 3 to 5 years, so this model breaks that mold and keeps them current.
Secondly, this process is different because we'll be using various digital platforms to host guideline recommendations and their supporting evidence. That means that these living recommendations can be rapidly and efficiently modified and updated. These platforms are multi-layered, meaning
that end-users have the option to drill down into details and data supporting the recommendations as needed. This personalized approach allows for more actionable and useful recommendations.
In addition, these guidelines will adhere to the highest methodological standards used in other healthcare disciplines, which means they will be transferable and acceptable to other interest-holders. For example, if we develop a guideline on pain management, emergency medicine can also use it because it's developed with the same methodological framework used in medicine.
Finally, guideline topics and priorities are being defined by an advisory panel made up of interest-holders across the U.S. oral health system. Having representation across different sectors is a new and important part of the process when determining areas for the most impactful guideline development.
The technology and methodological applications used in a living guideline model have advanced tremendously over the past five years, accelerated by the pandemic when new evidence needed to be quickly identified, assessed, and communicated to decision makers.
Machine-learning technology has developed so fast — the artificial intelligence (AI) technology supporting the living guideline program maps all available biomedical databases, looking for evidence on a daily basis. So, living guidelines are proactive — new evidence is being identified and incorporated into the knowledge base as it is published, and in turn, evaluated to determine if it warrants a change in guideline recommendations.
FOR THIS PROGRAM, WHAT ARE THE STEPS IN THE GUIDELINE DEVELOPMENT PROCESS?
An advisory panel will prioritize guideline topics for the program. That panel will consider a range of criteria — such as disease burden, availability of evidence, interventions that may be very effective but underutilized, cost, equity – and decide where the guideline development efforts can produce the highest value for the profession and for patients.
We then will look for the evidence behind those selected topics, conducting systematic reviews of the research — this is where we at CIGOH will be doing most of our work. A summary of the evidence identified in those reviews goes to a guideline panel — different from the advisory panel — to determine which guideline recommendations should be formulated.
The guideline panel will also be the one to review new evidence as it becomes available to determine whether a change to a recommendation is warranted. Not every update will warrant a change. In making that determination, the guideline panel will look at what the research tells us and the context where the recommendations are used — for example, sometimes coverage decisions change with insurance companies or Medicaid. We'll be monitoring both aspects, and the findings will be presented to the guideline panel for quick review and decision-making on any possible changes to recommendations.
WILL THE PROGRAM INVOLVE ONLY NEW GUIDELINES OR WILL EXISTING GUIDELINES BE REVIEWED AS WELL?
Along with new topics, the advisory panel will be looking at existing guidelines to revisit and update as well. Some existing guidelines have vague language, so in particular, those are the types we anticipate would be selected for review.
“The purpose of creating a guideline is to get better health outcomes. Through this program, our goal is to not only achieve that but also increase the certainty of those health outcomes.”
— DR. ALONSO CARRASCO-LABRA
HAVE THE FIRST ROUND OF GUIDELINE TOPICS BEEN SELECTED YET?
The advisory panel met for the first time at the end of March 2025. Its first focus will be an update of a 2017 ADA guideline on the evaluation of potentially malignant disorders and oral squamous cell carcinoma in the oral cavity. The guideline panel is being formed as we speak, and the first recommendation is expected to publish digitally later this year.
WHY IS GUIDELINE DEVELOPMENT SO IMPORTANT?
The purpose of creating a guideline is to get better health outcomes. Through this program, our goal is to not only achieve that but also increase the certainty of those health outcomes.
The research evidence by itself does not tell clinicians how to proceed in practice. There is a space between what the data shows and the decision on whether something needs to be done in the face of that data. That’s the space the guideline panel feeds — they bring the context, they interpret the data, and put all that together and come up with the recommendations. In the face of new research and technologies, guideline users just want to know what to do, and guidelines meet that need.
WHERE CAN THE GUIDELINES BE ACCESSED ONCE PUBLISHED?
The guidelines will be available online in The Journal of the American Dental Association, and quarterly updates to the guideline will be published and available in JADA and on www.ADA.org.

The program also has the potential to help identify areas in need of more research. For example, when we conduct systematic reviews on a guideline topic, we may find there's not a lot of evidence to inform a particular clinical or public health issue. Through that process, we can identify the specific type of research needed to develop more robust and better guidelines in the future.
WHY IS CIGOH SUCH AN APPROPRIATE COLLABORATOR FOR THIS GUIDELINE PROGRAM?
The guideline program fits into the way the Center was envisioned from the beginning. Part of our mission and vision for CIGOH is to support clinicians and public health practitioners. What better way to do that than by keeping guideline users up to date on the science behind the care they provide and decisions they make. Plus, we have the methodological and technical expertise and experience working globally on guideline development and systematic reviews through the work of our Cochrane Oral Health Collaborating Center. We are adding faculty and staff members to CIGOH to support the program and are eager to work with the ADA and interest-holders across disciplines to bring this new level of guidance to oral healthcare. n
The Penn Dental Medicine research enterprise spans scientific disciplines to translate new knowledge into clinical therapies that are expanding our understanding of disease and advancing patient care. In 2024, faculty and research staff continued to move scholarship forward across their respective fields and beyond. On the pages that follow, we highlight some of these research and scholarly activities for 2024.
Following are the total funds (direct and indirect, above $50K) spent by Penn Dental Medicine faculty/principal investigators in the 2024 calendar year.
FACULTY/DEPARTMENT
Dr. Kelly Jordan-Sciutto, Oral Medicine
Dr. George Hajishengallis, Basic & Translational Sciences
Dr. Dana T. Graves, Periodontics
Dr. Hyun (Michel) Koo, Orthodontics/COH/Pediatrics
Dr. Gary H. Cohen, Basic & Translational Sciences
Dr. Shuying (Sherri) Yang, Basic & Translational Sciences
Dr. Geelsu Hwang, Preventive & Restorative Sciences
Dr. Temitope Omolehinwa, Oral Medicine
Dr. Marco Tizzano, Basic & Translational Sciences
Dr. Hydar Ali, Basic & Translational Sciences
Dr. Yu Zhang, Preventive & Restorative Sciences
Dr. David Hershkowitz, Preventive & Restorative Sciences
Dr. Bruce J. Shenker, Basic & Translational Sciences
Dr. Robert P. Ricciardi, Basic & Translational Sciences
Dr. Chider Chen, Oral Surgery
Dr. Sunday Akintoye, Oral Medicine
$2,807,316
$1,621,811
$1,490,187
$1,470,225
$1,325,834
$1,160,313
$881,342
$812,931
$746,672
$691,728
$642,676
$616,708
$605,174
$547,075
$536,484
$517,829
Dr. Kyle Vining, Preventive & Restorative Sciences $472,584
Dr. Anh Le, Oral Surgery
$463,610
Dr. Kang Ko, Periodontics $394,604
Dr. Henry Daniell, Basic & Translational Sciences $389,798
Dr. Cagla Akay-Espinoza, Oral Medicine
Dr. Miriam Robbins, Oral Medicine $293,737 FACULTY/DEPARTMENT
$338,721
Dr. Thomas Sollecito, Oral Medicine
$265,823
Dr. Eric Larson, Basic & Translational Sciences $197,776
Dr. Claire H. Mitchell, Basic & Translational Sciences $188,879
Dr. Kathleen Boesze-Battaglia, Basic & Translational Sciences $186,326
Dr. Flavia Teles, Basic & Translational Sciences $186,291
Dr. Mark S. Wolff, Preventive & Restorative Sciences $168,293
Dr. Chenshuang Li, Orthodontics $159,437
Dr. Esra Sahingur, Periodontics $158,464
Dr. Modupe Coker, Basic & Translational Sciences $146,407
Dr. Katherine Theken, Oral Surgery $143,199
Dr. Joan Gluch, Community Oral Health (COH) $134,271
Dr. Taewan Kim, Periodontics $129,639
Dr. Zhi Ren, Orthodontics $109,066
Dr. Catharina Grubaugh, Basic & Translational Sciences $100,612
Dr. Lindsay Festa, Oral Medicine $93,803
Dr. Yuan Liu, Basic & Translational Sciences $80,246
Dr. Yoosung Suh, Pediatrics $72,497
Dr. Yu Cheng Chang, Periodontics $69,435
Dr. Myra Laird, Basic & Translational Sciences $67,687
Dr. Anuradha Dhingra, Basic & Translational Sciences $66,960
Dr. Eugene Ko, Oral Medicine $52,760
In 2024, the following new grants of $150,000 and above were awarded to Penn Dental Medicine faculty.
Oligodendrocyte Damage and Dysfunction in HIV-Associated Neurocognitive Disorder
Principal Investigator: Dr. Kelly L. Jordan-Sciutto, Oral Medicine (NIH; Total Award $3,810,512, 4 years)
Mechanisms of Variability in the Analgesic Response to Ibuprofen Following Third Molar Extraction
Principal Investigator: Dr. Katherine N. Theken, Oral & Maxillofacial Surgery/Pharmacology (NIH; Total Award $3,446,546, 5 years)
Defining Dysbiosis and Mechanisms of Periodontitis Progression and Stability
Principal Investigator: Dr. Flavia Teles, Basic & Translational Sciences (NIH; Total Award $3,026,992, 5 years)
HPV, HIV and Oral Microbiota Interplay in Nigerian Youth (HOMINY)
Principal Investigator: Dr. Modupe Coker, Basic & Translational Sciences (NIH; Total Award $2,827,853, 3 years)
INPP5E Signaling and Treatment in Rheumatoid Arthritis
Principal Investigator: Dr. Shuying Yang, Basic & Translational Sciences (NIH; Total Award $2,791,039, 5 years)
Stromal Effects in Head and Neck Squamous Cell Carcinoma
Principal Investigator: Dr. Chider Chen, Oral & Maxillofacial Surgery/ Pharmacology (NIH; Total Award $1,858,595, 5 years)
Clonal Hematopoiesis and Periodontal Disease
Principal Investigator: Dr. George Hajishengallis, Basic & Translational Sciences (NIH; Total Award $1,726,565, 5 years)
Development of a Peptide-Drug Conjugate for Topically Treating the Viral Skin Disease Molluscum Contagiosum
Principal Investigator: Dr. Robert P Ricciardi, Basic & Translational Sciences (FCCDC- NIH; Total Award $1,100,000, 3 years)
mRNA-LNP Vaccine Platform
Principal Investigator: Dr. Gary Cohen, Basic & Translational Sciences (BioNTech; Total Award $795,153, 1 year)
Targeting Mechanical Dysregulation of Stromal-Myeloid Crosstalk in Jak2Mediated Myeloproliferative Neoplasms
Principal Investigator: Dr. Kyle Vining, Preventive & Restorative Sciences (American Cancer Society; Total Award $792,000, 3 years)
Producing an Optimized Stapled Peptide that specifically Targets HSV-1 to Treat Herpes Ocular Keratitis
Principal Investigator: Dr. Robert P. Ricciardi, Basic & Translational Sciences (FCCDC- NIH; Total Award $447,868, 1 year)
Role of a Novel G Protein-Coupled Mast Cell Receptor-Mediated Pathways in Periodontal Disease
Principal Investigator: Dr. Hydar Ali, Basic & Translational Sciences (NIH; Total Award $446,875, 2 years)
Repurposing Ferumoxytol Nanoparticles to Promote Orofacial Stem Cell Function for Autotherapies
Principal Investigator: Dr. Chider Chen, Oral & Maxillofacial Surgery/ Pharmacology (NIH; Total Award $446,876, 2 years)
Ryan White Part A CARE Services-AACO
Principal Investigator: Dr. Miriam R. Robbins, Oral Medicine (AACO- City of Philadelphia; Total Award $432,000, 1 year)
Characterize Longitudinal Events of oHR-HPV Among an At-Risk Population (CLEAR) Study
Principal Investigator: Dr. Modupe Coker, Basic & Translational Sciences (UMB-National Institutes of Health; Total Award $329,412, 5 years)
Overcoming Resistance to CAR T-cell Therapy in Acute Leukemia by Targeting Mechanical Regulation in Fibrosis
Principal Investigator: Dr. Kyle Vining, Preventive & Restorative Sciences (Hartwell Foundation; Total Award $300,000, 3 years)
Collaborative Research: Multiscale Analyses of Longitudinal Human Dental Wear
Principal Investigator: Dr. Myra Laird, Basic & Translational Sciences (National Science Foundation; Total Award $298,025, 3 years)
Pharmacologic Approaches to Enhance Lysosomal Function in Cells with ATP6AP2 Mutations
Principal Investigator: Dr. Claire Mitchell, Basic & Translational Sciences (Luka Shai Foundation; Total Award $288,000, 1 year)
Probing the Role of Selenomonas Sputigena in Supragingival Biofilm Spatial Structuring and Virulence
Principal Investigator: Dr. Zhi Ren, Orthodontics (NIH; Total Award $243,324, 2 years)
Uncovering the Biological Link between Oral and Mental health in Adolescents Living with HIV (uBLOoM)
Principal Investigator: Dr. Modupe Coker, Basic & Translational Sciences (NIH; Total Award $181,450, 1 year)
PlumX Metrics capture how people interact with research publications, including output citations, mentions, and social media presence. Below is a selection of faculty publications published between 2019 and 2024 with the PlumX scores for those papers.
AUTHOR/DEPARTMENT TITLE
JOURNAL YEAR OF
(1ST OR SENIOR AUTHOR BOLDED) PUBLICATION SCORE
Zheng S, Bawazir M, Dhall A, Kim HE, Implication of Surface Properties, Bacterial Motility, Front Bioeng 2021 1089 He L, Heo J, Hwang G. and Hydrodynamic Conditions on Bacterial Biotechnol. (Preventive & Restorative Sciences) Surface Sensing and Their Initial Adhesion
Hajishengallis G, Chavakis T. Local and systemic mechanisms linking periodontal Nat Rev Immunol. 2021 776 (Basic & Translational Sciences) disease and inflammatory comorbidities
Urquhart O, Tampi MP, Pilcher L, Nonrestorative Treatments for Caries: J Dent Re.s 2019 579 Slayton RL, Araujo MWB, Fontana M, Systematic Review and Network Meta-analysis Guzmán-Armstrong S, Nascimento MM, Nový BB, Tinanoff N, Weyant RJ, Wolff MS, Young DA, Zero DT, Brignardello-Petersen R, Banfield L, Parikh A, Joshi G, Carrasco-Labra A. (Preventive & Restorative Sciences)
Graves DT, Corrêa JD, Silva TA. The Oral Microbiota Is Modified by J Dent Res. 2019 496 (Periodontics) Systemic Diseases
Blatz MB, Conejo J. The Current State of Chairside Digital Dent Clin North Am. 2019 438 (Preventive & Restorative Sciences) Dentistry and Materials
Kligman S, Ren Z, Chung CH, Perillo MA, The Impact of Dental Implant Surface J Clin Med. 2021
Chang YC, Koo H, Zheng Z, Li C. Modifications on Osseointegration (Orthodontics) and Biofilm Formation
Matsumoto K, Sherrill-Mix S, A cone-beam computed tomographic evaluation
Boucher N, Tanna N. of alveolar bone dimensional changes and the (Orthodontics) periodontal limits of mandibular incisor advancement inskeletal Class II patients
Hwang G, Paula AJ, Hunter EE, Liu Y, Catalytic antimicrobial robots for Sci Robot. 2019 344 Babeer A, Karabucak B, Stebe K, biofilm eradication
Kumar V, Steager E, Koo H. (Orthodontics/COH/Pediatrics)
Hersh EV, Moore PA, Grosser T, Nonsteroidal Anti-Inflammatory Drugs J
Polomano RC, Farrar JT, Saraghi M, and Opioids in Postsurgical Dental Pain Juska SA, Mitchell CH, Theken KN. (Oral Surgery & Pharmacology)
Kolakarnprasert N, Kaizer MR, New multi-layered zirconias: Composition, Dent Mater
Kim DK, Zhang Y microstructure and translucency (Preventive & Restorative Sciences)
Setzer FC, Shi KJ, Zhang Z, Yan H, Artificial Intelligence for the Computer-aided J Endod
Yoon H, Mupparapu M, Li J. Detection of Periapical Lesions in Cone-beam (Endodontics) Computed Tomographic Images
Vining KH, Stafford A, Mooney DJ. Sequential modes of crosslinking tune Biomaterials. 2019 224 (Preventive & Restorative Sciences) viscoelasticity of cell-instructive hydrogels
AUTHOR/DEPARTMENT TITLE
(1ST OR SENIOR AUTHOR BOLDED)
Safi C, Kohli MR, Kratchman SI, Outcome of Endodontic Microsurgery Using Mineral J Endod
191 Setzer FC, Karabucak B. Trioxide Aggregate or Root Repair Material as Root(Endodontics) end Filling Material: A Randomized Controlled Trial with Cone-beam Computed Tomographic Evaluation
Kim D, Lee AE, Xu Q, Zhang Q, Le AD Gingiva-Derived Mesenchymal Stem Cells: Potential Front Immunol.
(Oral Surgery & Pharmacology) Application in Tissue Engineering and Regenerative Medicine: A Comprehensive Review
Panchal N, Mahmood L, Retana A, Dynamic Navigation for Dental
Emery R 3rd. (Oral Surgery & Pharmacology) Implant Surgery
Daniell H, Jin S, Zhu XG, Gitzendanner MA, Green giant-a tiny chloroplast genome
Soltis DE, Soltis PS. with mighty power to produce high-value (Basic & Translational Sciences) proteins: history and phylogeny
Ko KI, Sculean A, Graves DT. (Periodontics) Diabetic wound healing in soft and hard oral tissues Transl Res.
Setzer FC, Lee SM. (Endodontics)
Bond S, Lopez-Lloreda C, Gannon PJ, The Integrated Stress Response and
Akay-Espinoza C, Jordan-Sciutto KL Phosphorylated Eukaryotic Initiation (Oral Medicine) Factor 2α in Neurodegeneration
Kattimani V, Lingamaneni KP, Use of eggshell-derived nano-hydroxyapatite J
Yalamanchili S, Mupparapu M as novel bone graft substitute: A randomized (Oral Medicine) controlled clinical study
Dr. George Hajishengallis,
Dr. Hyun (Michel) Koo, Orthodontics/COH/Pediatrics
Dr. Alonso Carrasco Labra,
The impact of faculty publications measured by the h index* is presented for a selection of faculty – those with the top h index figures for the past five years. * The h-index was developed by J.E. Hirsch, Department of Physics, UCSD and attempts to measure the impact of an individual’s publications. As an example, an h-index of 20 means there are 20 publications that have 20 citations or more each in journals covered by the Scopus database.
Following is a selection of original research articles of high impact published in 2024 by Penn Dental Medicine faculty as first or senior authors (in bold).
AUTHORS/DEPARTMENT
Wang H., Divaris K., Pan B., Li X., Lim J.-H., Saha G., Clonal hematopoiesis driven by mutated Cell 45.6 Barovic M., Giannakou D., Korostoff J.M., Bing Y., Sen S., DNMT3A promotes inflammatory bone loss Moss K., Wu D., Beck J.D., Ballantyne C.M., Natarajan P., North K.E., Netea M.G., Chavakis T., Hajishengallis G. (Basic & Translational Sciences)
Oh, M.J., Yoon, S., Babeer, A., Liu, Y., Ren, Z., Xiang, Z., Nanozyme-Based Robotics Approach for Advanced 27.4 Miao, Y., Cormode, D.P., Chen, C., Steager, E., Koo, H. Targeting Fungal Infection Materials (Orthodontics/COH/Pediatrics)
Yang, B., Alimperti, S., Gonzalez, M.V., Dentchev, T., Reepithelialization of Diabetic Skin and Diabetes 6.2 Kim, M., Suh, J., Titchenell, P.M., Ko, K.I., Seykora, J., Mucosal Wounds Is Rescued by Treatment Benakanakere, M., Graves, D.T. (Periodontics) With Epigenetic Inhibitors
Tanum, J., Kim, H.E., Lee, S.M., Kim, A., Korostoff, J., Photobiomodulation of Gingival Cells Journal of 5.7 Hwang, G. (Preventive & Restorative Sciences) Challenged with Viable Oral Microbes Dental Research
Theken, K.N., Hersh, E.V. Cannabidiol for Toothache: Ups, Downs, Journal of 5.7 (Oral Surgery & Pharmacology) and Regulatory Considerations Dental Research
Kim WS, Prasongyuenyong K, Ko A, Debnath R, Chen Z, ICAM1(+) gingival fibroblasts modulate Front Immunol 5.7 Zhou JX, Shaaf E, Ko KI. periodontal inflammation to mitigate bone loss (Periodontics)
Bawazir, M., Lim, C.H., Arnés-Urgellés, P., Lu, M., Huang, H., Brittle–Ductile Threshold in Lithium Disilicate Journal of 5.7 Zhang, Y. (Preventive & Restorative Sciences) under Sharp Sliding Contact Dental Research
Lim J.-H., Neuwirth A., Chung K.-J., Grossklaus S., Formyl peptide receptor 2 regulates dendritic Frontiers in 5.7 Soehnlein O., Hajishengallis G., Chavakis T. cell metabolism and Th17 cell differentiation Immunology (Basic & Translational Sciences) during neuroinflammation
Alzoubi, F., Alajmi, S., Alkandari, A., Alqahtani, S., Post-operative pain in non-surgical root International 5.4 Alanezi, A., Setzer, F.C. (Endodontics) canal treatment after sealer-based obturation Endodontic versus warm vertical compaction: Journal A randomized clinical trial

$20.4M
RESEARCH FUNDING SPENT IN FY24
206
RESEARCH PUBLICATIONS AUTHORED BY FULL-TIME FACULTY IN 2024
Contributed by Dr. Joan Gluch, Professor of Clinical Community Oral Health
Although the Centers for Disease Control and Prevention named community water fluoridation as one of the top ten greatest public health achievements of the twentieth century, many federal and state officials have recently challenged the safety of water fluoridation, creating doubt among many community members. Many dentists report that their patients ask questions about the safety and efficacy of all fluoride products, not just water fluoridation, and refuse any fluoride for themselves and their children because of the negative reports in the popular press.
Now, more than ever, it is crucial for dentists and their staff to defend fluoride and answer patients’ questions in clear and concise terms emphasizing safety and disease prevention. Studies consistently show that communities with fluoridated water experience fewer cavities than those without it. For example, a Centers for Disease Control and Prevention (CDC) review found that water fluoridation reduces cavity incidence by 25% across all age groups.
Dentists should first listen to their patient’s concerns and tailor the message, including personal experiences about the positive benefits of fluoride to build trust. When safety is a concern, dentists should provide information about the rigorous U.S. safety standards because studies that suggest a link between high fluoride exposure and reduced IQ scores were done in other countries that exceed the U.S.-regulated amount of .7 mg fluoride in municipal water. Although these studies are important to identify safety concerns with excessive amounts of fluoride, they do not apply to the conditions of U.S. water fluoridation. Since fluoride is a naturally occurring mineral commonly found in rocky soils, nearly all U.S. water contains some fluoride. When the naturally occurring fluoride levels are not

high enough to reduce dental decay, communities add the right amount of fluoride to reach the desired .7 mg level.
Water fluoridation is one of the most cost-effective public health interventions available. The CDC estimates that every dollar spent on water fluoridation saves approximately $38 in dental treatment costs. This is because preventing cavities through fluoridation reduces the need for dental treatments, which can be expensive and inaccessible for many people. The cost savings are particularly significant for low-income communities, where access to dental care may be limited. By investing in water fluoridation, communities can reduce healthcare costs and improve the overall health of their residents.
Because some patients equate concerns with water fluoridation with all fluoride products, dentists should highlight the advantages and low-risk profile of topical fluoride treatments. Unfortunately, many patients are eliminating all fluoride products due to
“Water fluoridation is one of the most cost-effective public health interventions available. The CDC estimates that every dollar spent on water fluoridation saves approximately $38 in dental treatment costs. ”
— DR. JOAN GLUCH
the negative associations reported regarding water fluoridation. Dentists should ensure that patients understand the role of systemic and topical fluorides as key elements in dental decay prevention.
Dentists have an essential role in educating their patients regarding the many benefits of water fluoridation and all fluoride products to reduce dental decay and improve oral health. Water fluoridation is a crucial preventive measure for community oral health. It plays a vital role in improving the overall health of communities by preventing dental caries, reducing healthcare costs, and addressing oral health disparities. Community water fluoridation is safe, effective, and cost-efficient, making it an essential component of public health strategies promoting oral health. Dentists should recommend the U.S. website http://www.ilikemyteeth.org, which provides consumer-friendly information that is easily accessible to all for further information.
TELES, DDS, MS, DMSC, IS TAKING A MICROBIOLOGIST’S LENS TO ORAL HEALTH, UNCOVERING HIDDEN CAUSES OF DISEASES.
JUST INSIDE DR. FLAVIA TELES’ LAB are four oversized freezers, so large they line an entire wall. They’re a commanding presence. Their size aligns with the importance of their job: They contain more than 300,000 samples that Teles and her team have collected —bits of saliva, blood, gingival fluid, and plaque from people suffering from periodontitis. The samples in this biobank are key to Teles’ work, so much so that if the temperature rises above minus 80 C degrees, an alarm sounds and Teles and her lab members receive warnings via text message and email.

ABOVE: Ashley Kang
“These samples are very precious,” Teles says. “They are central to our research and vital to helping us better understand the progression of disease, stability, and response to treatment.”
Teles, Associate Professor in the Department of Basic & Translational Sciences, views oral health through a microbiologist’s eyes, uncovering the relationship between the microbes that live in the mouth, the immune responses they elicit, and the diseases that afflict the mouth and beyond. The biobank is elucidating the factors that make certain people or teeth vulnerable to severe damage from periodontitis — and which, if any, protect against it.
With the biobank and beyond, Teles is working to characterize the 50 percent of the oral microbiome that remains unclassified and may be important players in health and disease. She’s developed new models to cultivate microorganisms, enabling her to sequence them and test new antimicrobials. In addition to treating periodontitis, her work is illuminating the ways oral disease contributes to other conditions such as atherosclerosis and cancer, including in people with a rare genetic disease called Fanconi anemia (FA).
Growing up in Rio de Janeiro, Brazil, Teles was surrounded by dentistry. Her grandfather, aunt, and uncle were all dentists. She earned her DDS at the Federal University of Rio de Janeiro and received a certificate in periodontology from the Pontifical Catholic University Dental Institute. During that time, she interacted with clinicians who had studied internationally and brought new knowledge home to help their communities, experiencing firsthand the impactful intersection of science and clinical care.
“I wanted to be part of that,” Teles says. “I wanted to be part of generating the knowledge, passing the knowledge along, and making the field better ultimately.”
Teles decided to pursue research. She received an M.S. in periodontology from the State University of Rio de Janeiro and went on to earn a Doctor of Medical Sciences in oral biology from the Harvard School of Dental Medicine, followed by a postdoctoral fellowship in oral microbiology at the Forsyth Institute. Her path as an investigator continued as part of the faculty of Harvard and as a researcher at Forsyth. Teles joined Penn Dental Medicine from the University
grows bacterial and fungal species in the Teles lab as part of her Basic and Translational Sciences Honors project.
OPPOSITE: Dr. Flavia Teles, Associate Professor in the Department of Basic & Translational Sciences at Penn Dental Medicine, is working to characterize the 50 percent of the oral microbiome that remains unclassified and may be important players in health and disease.

of North Carolina at Chapel Hill School of Dentistry in 2017.
As early as the 1960s, researchers began to link oral bacteria with gingivitis. But those researchers didn’t have today’s advanced sequencing technologies. Now, researchers like Teles can identify and count individual microbes in a given sample, painting a precise picture of the microbial environments that both prevent and catalyze disease.
With the new technologies in hand, Teles collaborated with researchers at the Forsyth Institute, New York University, State University of New York at Buffalo, the University of Michigan, and Southern Illinois University to amass the samples that now sit in her freezers. They enrolled more than 400
people, taking bloodwork and other clinical data every two months for a year. They also checked periodontal parameters at six spots, or sites, per tooth for up to 28 teeth. They then treated participants who developed periodontitis and followed up with them three and six months later.
By analyzing the microbes in her biobank and the immune responses associated with them, Teles is beginning to uncover links between the microbiome and worsening disease. In one analysis, she found that people with periodontitis have abnormally high levels of some pathogenic microbes that naturally occur in the mouth, a disruption of the microbiome known as dysbiosis. She is currently expanding on this line of study
“I wanted to be part of generating the knowledge, passing the knowledge along, and making the field better ultimately.”
— DR. FLAVIA TELES
with support from the National Institute of Dental and Craniofacial Research (NIDCR), looking to define the precise nature of this dysbiosis. She is pursuing this work in collaboration with Dr. Kyle Bittinger, an Assistant Professor in the Division of Gastroenterology, Hepatology, and Nutrition, Children’s Hospital of Philadelphia and the Analytical Core Lab Director of the PennCHOP Microbiome Center. Bittinger is an expert in bioinformatic approaches to measure and model the human microbiome, particularly through the analysis of high-throughput DNA sequencing data.
Dysbiosis seems to cause a disconnect between clinical appearance in the mouth and the possibility of worsening periodontal disease. In the patients in her biobank, some sites appeared healthy before undergoing bursts of breakdown; others looked unhealthy but remained stable.
“You wouldn’t know if you didn’t follow them over time,” Teles says. “Now because we have samples and we can follow them over time, we can say, ‘With those areas that ultimately went downhill, what was happening before the clinical benchmark of disease? What are the microbial markers, what were the host mediators, what were the metabolites? How were all those things interacting so that ultimately something that looked fine was not fine?’”
Some hints are already emerging. People with periodontitis have more proinflammatory molecules in their saliva, Teles has found. Even after treatment, the inflammatory marker levels go down but never get as low as in people without the disease, suggesting periodontitis sufferers may be prone to systemic inflammation.
In addition to signs of areas at risk for disease, the work could also point to microbes, metabolites, or other molecules that make the gums resistant to damage. Those molecules could then be leveraged as treatments.
“Hopefully one day, we can have a saliva test that analyzes a couple of bacteria and proteins to tell you your risk of periodontal disease,” Teles says. “This would be for me the holy grail.”

In January, the NIH named Penn one of five schools selected to be a Virome Characterization Center (VCC), awarding the University a $20 million grant that supports cataloguing the many viruses that call the human body home. Teles was tapped to lead the dental medicine portion of Penn’s VCC.
The Penn virome effort is a joint one, involving researchers from Penn Medicine, CHOP, and Penn Dental Medicine. In the first, five-year phase of the project, researchers will focus on identifying and categorizing viruses found in the gut, blood, respiratory tract, and mouth — the latter the principal responsibility of Teles and her Penn Dental Medicine team.
“The lead investigators from Penn Medicine and CHOP and I have been working as a team from the get-go — it’s a very well-integrated effort across the three institutions,” Teles said.
The work is in many ways an extension of Teles’ biobank. Much as the biobank characterizes the spectrum of microbes living in the human mouth, and the virome project will identify the viruses that commonly live in human beings. Teles will oversee the collection of new samples, which will be analyzed for viral genetic sequences. The participants will also provide lifestyle
data — diet, exercise, medical conditions, and more — to help identify links between the virome and disease.
“Typically, studies of viruses in human samples have been targeted toward specific viruses or sets of viruses, but this is going to be an open-ended search in largely uncharted territory—an investigation of unprecedented breadth,” Teles said. “We want to discover the full panoply of viruses that are carried by normal, walking-around individuals.”
Teles’ penchant for collaboration was also on display in August, when she and Dr. Shefali Setia Verma, Assistant Professor of Pathology and Laboratory Medicine at Perelman School of Medicine, were selected as inaugural winners of the Artificial Intelligence in Oral Health Innovation Award. This grant from the Center for Innovation and Precision Dentistry (CiPD) and the Penn Institute for Biomedical Informatics supports collaborative research that uses artificial intelligence (AI) to address issues in oral-craniofacial health sciences.
Their project will harness AI-based approaches to integrate and analyze genetic, immunological, and clinical data along with demographic information to build models that predict the likely course of periodontitis in an individual. With such predictive models, patients could be evaluated at a
“Typically, studies of viruses in human samples have been targeted toward specific viruses or sets of viruses, but this is going to be an open-ended search in largely uncharted territory — an investigation of unprecedented breadth.”
— DR. FLAVIA TELES
community center or general dentistry practice and avoid unnecessary specialist visits, Teles explains — or, if needed, obtain specialty care more quickly.
“They can assess their risk where they are,” Teles says. “This way we will be able to allocate resources much, much better.”
Teles is also leveraging the oral microbiome to help improve the lives of people with Fanconi anemia (FA), a rare genetic disease that greatly increases the risk of cancer, particularly in the mouth. Children with the disease sometimes develop oral cancer as young as 10 years old — “basically unheard of” in the general population, Teles says. In fact, in FA patients, screening of the oral cavity should start prior to 15 years of age. And because the disease attacks the body’s ability to repair DNA, people with FA can’t undergo typical radiation and chemotherapy.
Teles’ research suggests that the oral microbiome contributes to cancer risk in people with FA. “Finding a way to decrease their risk for the oral component, at least, would be a huge help for patients and their families,” Teles says.

SUPPORTING THE NEXT GENERATION
Teles’ drive to help others is not limited to finding solutions to improve patient care. She’s also committed to supporting young scientists in their careers. Her lab includes students at varying stages of their education — from undergraduates at Penn to DMD students, residents and postdocs.
As a core member of Penn Dental Medicine’s CiPD, the joint center with Penn Engineering, and Chair of its executive committee, she is also a coinvestigator on CiPD’s NIDCR-funded postdoctoral training program and serves as a mentor for program fellows. The program aims to create a new generation of interdisciplinary researchers at the intersection of dentistry and engineering to accelerate discovery, innovation, and translation to address unsolved problems in oral and craniofacial health.
Teles also serves as a mentor for the American Association for Dental, Oral, and Craniofacial Research (AADOCR)’s Mentoring an Inclusive Network for a Diverse Workforce of the Future (MIND the Future) program. The primary goal of this NIDCR-funded program is to establish a mentoring network that will support up-and-coming investigators in developing independent research careers.
Teles’ commitment to supporting early-career researchers originates in part from one of her own mentors at the Forsyth Institute, Anne Haffajee. At the time, Haffajee was the only woman to ever chair a department at Forsyth. When writing one of her first grants, Teles had to explain why she chose to work with Haffajee. She recalls writing, “I can relate to her, and I want to be just like her.”
Teles admired how Haffajee raised two daughters and supported students while pursuing her successful academic career. (Her own 17-year-old daughter is currently considering a career in neuroscience.) In 2013, after Haffajee passed away from cancer at the age of 65, Teles wanted to honor her legacy by creating a new opportunity for women pursuing dental science. In partnership with AADOCR, she raised $125,000 to create the first endowed fellowship offered by the association.
Since its launch in 2017, the Anne D. Haffajee Fellowship has awarded $10,000 each to eight women, many of whom used the funds to support work that earned them their first federal funding, Teles notes.
“That’s something that I am very proud of,” says Teles. “It is inspiring to share the rewards of a career in research and discovery with the next generation. n
—By Laura Dattaro
BASIC & TRANSLATIONAL SCIENCES
NEWS/ACHIEVEMENTS
Dr. George Hajishengallis was named on the Highly Cited Researchers™ 2024 list from Clarivate in the cross-field category — the sixth time to be named to this list. This annual list identifies researchers who demonstrated significant influence in their chosen field or fields through the publication of multiple highly cited papers during the last decade.

Dr. Jong-Hyung Lim was the recipient of a first-place poster award at the 6th International Symposium on Trained Immunity/Innate Immune Memory, Dresden, Germany, for the project “DEL-1 is a novel endogenous senolytic protein that inhibits senescence-associated bone loss.”
A selection of published work (August 2024 – December 2024) by department researchers (indicated in bold).
Belibasakis GN, Hajishengallis G
Editorial: Proceedings of the 3rd international conference on oral mucosal immunity and microbiome. Frontiers in Oral Health. 2024;5. doi: 10.3389/ froh.2024.1469116.
Bijon J, Hussain MM, Bredefeld CL, Boesze-Battaglia K, Freund KB, Curcio CA. Abetalipoproteinemia with angioid streaks, choroidal neovascularization, atrophy, and extracellular deposits revealed by multimodal retinal imaging. Ophthalmic Genet. 2024. doi: 10.1080/13816810.2024.2411290.
Campagno KE, Sripinun P (Co-Author in Orthodontics), See LP (Co-Author in Endodontics), Li J, Lu W, Jassim AH, Más Gómez N, Mitchell CH. Increased Pan-Type, A1-Type, and A2-Type Astrocyte Activation and Upstream Inflammatory Markers Are Induced by the P2X7 Receptor. International Journal of Molecular Sciences. 2024;25(16). doi: 10.3390/ijms25168784.
Castro dos Santos N, Westphal MR, Retamal-Valdes B, Duarte PM, Figueiredo LC, Faveri M, Shibli J, Soares G, Miranda T, Fermiano D, Borges I, Goncalves C, Tanaka CJ, Teles F, et al. Influence of gender on periodontal outcomes: A retrospective analysis of eight randomized clinical trials. Journal of Periodontal Research. 2024. doi: 10.1111/ jre.13272.
Forman TE, Sajek MP, Larson ED, Mukherjee N, Fantauzzo KA. PDGFRα signaling regulates Srsf3 transcript binding to affect PI3K signaling and endosomal trafficking. Elife. 2024;13. Epub 20241204. doi: 10.7554/ eLife.98531.
Hajishengallis G, Chavakis T. Central trained immunity and its impact on chronic inflammatory and autoimmune diseases. Journal of Allergy and Clinical Immunology. 2024;154(5):1113-6. doi: 10.1016/j.jaci.2024.06.005.
Kepp KP, Aavitsland P, Ballin M, Balloux F, Baral S, Bardosh K, Bauchner H, Bendavid E, Bhopal R, Blumstein DT, Boffetta P, Bourgeois F, Brufsky A, Collignon PJ, Cripps S, Cristea IA, Curtis N, Djulbegovic B, Faude O, Flacco ME, Guyatt GH, Hajishengallis, G, et al. Panel stacking is a threat to consensus statement validity. Journal of Clinical Epidemiology. 2024;173. doi: 10.1016/j. jclinepi.2024.111428.
Lim JH, Neuwirth A, Chung KJ, Grossklaus S, Soehnlein O, Hajishengallis G, et al. Formyl peptide receptor 2 regulates dendritic cell metabolism and Th17 cell differentiation during neuroinflammation. Frontiers in Immunology. 2024;15. doi: 10.3389/ fimmu.2024.1354074.
Mulvaney R, Pan Y, Zhao N, Teles F, Lu J, Platz EA, et al. Blood Leukocyte DNA Methylation Markers of Periodontal Disease and Risk of Lung Cancer in a Case–Control Study Nested in the CLUE II Cohort. Cancer Epidemiol Biomarkers Prev. 2024;33(10):1339-46. doi: 10.1158/1055-9965.EPI-24-0279.
Polvadore TA, Yoakum CB, Taylor PM, Holmes MA, Laird MF, Chalk-Wilayto J, et al. Ontogenetic biomechanics of tufted (Sapajus) and untufted (Cebus) capuchin mandibles. American Journal of Biological Anthropology. 2024;185(2). doi: 10.1002/ajpa.25006.
Santos-Cortez RLP, Gomez HZ, Elling CL, Mayher L, Diala OR, Gardner C, Willford K, Zamora VC, Agyepong A, Lee NK, Green KK, Darr OA, Wine TM, Francom CR, Larson ED, et al. APOBR Is Downregulated in EBV+ Tonsils of Children with Obstructive Sleep-Disordered Breathing. Genes. 2024;15(10). doi: 10.3390/ genes15101324.
Sirisereephap K, Surboyo MDC, Rosenkranz AL, Terao Y, Tabeta K, Maeda T, Hajishengallis G, et al. Protocols for collecting mouse PDL cells and bone marrow cells, differentiation, and data analysis. STAR Protoc. 2024;5(3). doi: 10.1016/j. xpro.2024.103162
Sutradhar S, Ali H. Mast cell MrgprB2 in neuroimmune interaction in IgEmediated airway inflammation and its modulation by β-arrestin2. Frontiers in Immunology. 2024;15. doi: 10.3389/ fimmu.2024.1470016.
A study from the lab of Flavia Teles shows that measuring levels of key proteins in patients’ saliva may be a way to track periodontitis. They found that on average, patients who experienced progression of periodontitis showed substantially more elevated levels of nine inflammation-related signaling proteins in saliva. See the following article:
Teles FRF, Chandrasekaran G, Martin L, Patel M, Kallan MJ, Furquim C, Hamza T (Co-Author in Periodontics), Cucchiara AJ, Kantarci A, Urquhart O (Co-Author in Preventive & Restorative Sciences), et al. Salivary and serum inflammatory biomarkers during periodontitis progression and after treatment. Journal of Clinical Periodontology. 2024. doi: 10.1111/jcpe.14048.
NEWS/ACHIEVEMENTS
Dr. Meetu Kohli has been appointed President of the American Board of Endodontics.
A selection of published work (August 2024 – December 2024) by department researchers (indicated in bold).
Alzoubi F, Alajmi S, Alkandari A, Alqahtani S, Alanezi A, Setzer FC. Postoperative pain in non-surgical root canal treatment after sealer-based obturation versus warm vertical compaction: A randomized clinical trial. International Endodontic Journal. 2024;57(9):1168-79. doi: 10.1111/iej.14102.
Aminoshariae A, Azarpazhooh A, Fouad AF, Glickman GN, He J, Kim SG, Kishen A, Letra AM, Levin L, Setzer FC, et al. Insights Into the Oct 2024 Issue of the Journal of Endodontics. Journal of Endodontics. 2024;50(10):1367-9. doi: 10.1016/j.joen.2024.09.003.
Aminoshariae A, Azarpazhooh A, Fouad AF, Glickman GN, He J, Kim SG, Kishen A, Letra AM, Levin L, Setzer FC, et al. Insights into the September 2024 Issue of the Journal of Endodontics. Journal of Endodontics. 2024;50(9):1195-7. doi: 10.1016/j.joen.2024.07.014.
Aminoshariae A, Azarpazhooh A, Fouad AF, Glickman GN, He J, Kim SG, et al. Insights into the August 2024 Issue of the Journal of Endodontics. Journal of Endodontics. 2024;50(8):1033-5. doi: 10.1016/j.joen.2024.06.014.
Aminoshariae A, Azarpazhooh A, Fouad AF, Glickman GN, He J, Kim SG, Kishen A, Letra AM, Levin L, Setzer FC, et al. Insights Into the November 2024 Issue of the Journal of Endodontics. Journal of Endodontics. 2024. doi: 10.1016/j. joen.2024.10.007.
Chen RQ, Lee Y, Yan H, Mupparapu M (Co-Author in Oral Medicine), Lure F, Li J, Setzer FC. Leveraging Pretrained Transformers for Efficient Segmentation and Lesion Detection in Cone-Beam Computed Tomography Scans. Journal of Endodontics. 2024;50(10):1505-14.e1. doi: 10.1016/j.joen.2024.07.012.
Nagendrababu V, Gopinath VK, Arias A, Setzer FC, Kazandag MK, Kishen A, et al. Knowledge of undergraduate and postgraduate dental students about managing traumatic dental injuries based on the 2020 International Association of Dental Traumatology guidelines: A online survey of 10 dental schools from 10 countries. Dental Traumatology. 2024;40(5):586-98. doi: 10.1111/edt.12961.
Nagendrababu V, Pigg M, Duncan HF, Abbott PV, Fouad AF, Kruse C, Patel S, Rechenberg DK, Setzer FC, et al. PRIDASE 2024 guidelines for reporting diagnostic accuracy studies in endodontics: A consensus-based development. International Endodontic Journal. 2024;57(8):996-1005. doi: 10.1111/iej.14075.
Setzer FC, Li J, Khan AA. The Use of Artificial Intelligence in Endodontics. Journal of Dental Research. 2024;103(9):853-62. doi: 10.1177/00220345241255593.
Dr. Miriam Robbins has been inducted as a Fellow of The College of Physicians of Philadelphia.
Dr. Mel Mupparapu received the American Academy of Oral and Maxillofacial Radiology’s 12th Annual S. Julian Gibbs Memorial Oration Award.
A selection of published work (August 2024 – December 2024) by department researchers (indicated in bold).
Alamoudi WA, Abdelsayed RA, Sollecito TP, Alhassan GA, Kulkarni R, Bindakhil MA. Causes of Oral Granulomatous Disorders: An Update and Narrative Review of the Literature. Head and Neck Pathology. 2024;18(1). doi: 10.1007/ s12105-024-01678-7.
France K, Faist M, Kost D, Luo Y, Niu J, Seymour L, Cadet T. Perceptions of the role of dentists in human papillomavirus and COVID-19 vaccinations: Results of a cross-sectional validated survey of adults. Journal of the American Dental Association. 2024;155(10):871-80. doi: 10.1016/j.adaj.2024.07.016.



May 29, 2025 // Penn Dental Medicine
www.dental.upenn.edu/CiPDSymp
Ghura S, Beratan NR, Shi X, AlvarezPeriel E, Bond Newton SE, AkayEspinoza C, Jordan-Sciutto KL. Genetic knock-in of EIF2AK3 variants reveals differences in PERK activity in mouse liver and pancreas under endoplasmic reticulum stress. Scientific Reports. 2024;14(1). doi: 10.1038/s41598-02474362-z.
Jeyaraman P, Anbinselvam A, Akintoye SO. Differentially expressed extracellular matrix genes functionally separate ameloblastoma from odontogenic keratocyst. BMC Oral Health. 2024;24(1). doi: 10.1186/s12903-024-04866-7.
LaNoce E, Zhang DY, Garcia-Epelboim A, Su Y, Sun Y, Alepa G, Angelucci AR, Akay-Espinoza C, Jordan-Sciutto KL, et al. Exposure to the antiretroviral drug dolutegravir impairs structure and neurogenesis in a forebrain organoid model of human embryonic cortical development. Frontiers in Molecular Neuroscience. 2024;17. doi: 10.3389/ fnmol.2024.1459877.
Martínez-Ramírez J, Saldivia-Siracusa C, González-Pérez LV, Cuadra Zelaya FJM, Gerber-Mora R, Cabrera OFG, BolognaMolina R, Gilligan G, Delgado-Azañero W, Rajendra Santosh AB, GonzálezArriagada WA, Villarroel-Dorrego M, Rojas BV, Gallagher KPD, Tager EMJR, Aranda-Romo S, García-Heredia GL, Garcia EC, Hurtado I, Turcios CA, Espinal LPS, González RAM, Prado Ribeiro AC, Ribeiro-Rotta RF, Kowalski LP, Curado MP, Toporcov TN, Sollecito TP, et al. Barriers to early diagnosis and management of oral cancer in Latin America and the Caribbean. Oral Diseases. 2024;30(7):4174-84. doi: 10.1111/odi.14903.
Santos-Silva AR, Pedroso CM, Gueiros LAM, Ní Ríordáin R, Kerr AR, Farag A, Sollecito T, et al. Mapping the legacy of the World Workshop on Oral Medicine: a 35-year global bibliometric analysis. Oral Surgery, Oral Medicine, Oral Pathology and Oral Radiology. 2024;138(2):261-8. doi: 10.1016/j. oooo.2024.04.009.
Schlachetzki JC, Gianella S, Ouyang Z, Lana AJ, Yang X, O’Brien S, Challacombe JF, Gaskill PJ, Jordan-Sciutto KL, et al. Gene expression and chromatin conformation of microglia in virally suppressed people with HIV. Life Sci Alliance. 2024;7(10). Epub 20240726. doi: 10.26508/lsa.202402736.
Turkstani H, Alfaifi A, Ramachandran M, Bushra A, Stoopler E, France K
Severe manifestation of plasma cell mucositis in a patient with autism spectrum disorder: A unique overlap illustrating challenges with diagnosis and management. Special Care in Dentistry. 2024;44(6):1608-14. doi: 10.1111/scd.13053.
Wong K, Nadella S, Mupparapu M, Sethna C. Preventative dental practices and cardiometabolic health in adolescents. Quintessence international (Berlin, Germany: 1985). 2024;55(9):714-21. doi: 10.3290/j. qi.b5586051.
NEWS/ACHIEVEMENTS
Dr. Katherine Theken received the 2025 Darrell Abernethy Early-Stage Investigator Award from the American Society for Clinical Pharmacology and Therapeutics.
SELECTED PUBLICATIONS
A selection of published work (August 2024 – December 2024) by department researchers (indicated in bold).
Koga S, Gates JC, Peters SM, Cooper K. Intraosseous mandibular clear cell odontogenic carcinoma with predominant small round blue cells: a potential diagnostic pitfall. Oral Surgery, Oral Medicine, Oral Pathology and Oral Radiology. 2024;138(6):e120-e4. doi: 10.1016/j.oooo.2024.07.009.
Nadella S, Hartmann MM, He P, Bear A, Theken KN, Panchal NH Do Infectious Disease Consultations Improve Outcomes For Surgical Management Of Medication-Related Osteonecrosis Of The Jaw (MRONJ)? Journal of Oral and Maxillofacial Surgery. 2024;82(9):S25-S6. doi: 10.1016/j. joms.2024.06.050.
Singh S, Stocco G, Theken KN, Dickson A, Feng Q, Karnes JH, et al. Pharmacogenomics polygenic risk score: Ready or not for prime time? Clinical and Translational Science. 2024;17(8). doi: 10.1111/cts.13893.
Wang TT, Nadella S, Sakano T, Wang S, Burris BJ. The Rise of Glucagon-Like Peptide 1 Agonists: Considerations for Oral and Maxillofacial Surgery. Journal of Oral and Maxillofacial Surgery. 2024;82(8):888-90. doi: 10.1016/j. joms.2024.04.005.
Zeng J, Chen S, Li C, Ye Z, Lin B, Liang Y, Wang B,Ma Y, Chai X, Zhang X, Zhou K, Zhang Q, et al. Erratum: Mesenchymal stem/stromal cells-derived IL-6 promotes nasopharyngeal carcinoma growth and resistance to cisplatin via upregulating CD73 expression: Erratum. J Cancer. 2024;15(19):6418-9. Epub 20241015. doi: 10.7150/jca.104693.
Zhang R, Mu X, Liu D, Chen C, Meng B, Qu Y, Liu J, Wang R, Li C, Mao X, et al. Apoptotic vesicles rescue impaired mesenchymal stem cells and their therapeutic capacity for osteoporosis by restoring miR-145a-5p deficiency. Journal of Nanobiotechnology. 2024;22(1). doi: 10.1186/s12951-024-02829-2.
Dr. Michel Koo was named on the Highly Cited Researchers™ 2024 list from Clarivate. He was recognized in the microbiology category – the third year in a row for this recognition. This annual list identifies researchers who demonstrated significant influence in their chosen field or fields through the publication of multiple highly cited papers during the last decade.
A selection of published work (August 2024 – December 2024) by department researchers (indicated in bold).
Elabed I, Zheng Z (Co-Author in Periodontics), Zhang Y (Co-Author in Preventive & Restorative Science), Chung CH, Li C. The Mechanical and Clinical Properties of Customized Orthodontic Bracket Systems—A Comprehensive Review. Journal of Functional Biomaterials. 2024;15(10). doi: 10.3390/jfb15100299.
Li C, Azami N, Campos H, Chan M, Van AD, Tisot P, et al. Dental students’ Myers-Briggs Type Indicator personality profile in the past 50 years: Systematic review and meta-analysis. Journal of Dental Education. 2024. doi: 10.1002/ jdd.13660.
Mu Y, Tran HH, Xiang Z, Majumder A, Hsu E, Steager E, Koo H, et al. Spiky Magnetic Microparticles Synthesized from Microrod-Stabilized Pickering Emulsion. Small. 2024;20(42). doi: 10.1002/smll.202402292.
Steinbaum S, Kelso A, Dairi NF, Boucher NS, Yu W. Assessment of Condylar Changes in Patients with Degenerative Joint Disease of the TMJ After Stabilizing Splint Therapy: A Retrospective CBCT Study. Diagnostics. 2024;14(20). doi: 10.3390/ diagnostics14202331.
Tinanoff N, Banerjee A, Buzalaf MAR, Chen JW, Dhar V, Ekstrand KR, Fontana M, Innes N, Koo H, et al. Principles and care pathways for caries management in children: IAPD Rome forum. Int J Paediatr Dent. 2024;34(5):692-9. Epub 20240423. doi: 10.1111/ipd.13192.

Philadelphia — Penn Dental Medicine’s Dr. Chun-Hsi Chung, Professor of Orthodontics and Chauncey M. F. Egel Endowed Chair of the Department of Orthodontics, has been recognized for his leadership in the specialty with the Middle Atlantic Society of Orthodontists (MASO) 2024 Lifetime Achievement Award.
The Lifetime Achievement Award is given to a MASO member who, in the opinion of the MASO Board of Directors, has made significant contributions to his or her community of patients; has served with distinction as a member of the American Association of Orthodontists at the national, constituent and/or component level; has personally contributed to the betterment of the specialty of orthodontics; has taught in a graduate or undergraduate orthodontic program during his or her professional career; and/or has been associated with orthodontic research or has been an orthodontic staff member or consultant on a hospital staff.
Dr. Chung, who is also Director of the School’s postdoctoral program in orthodontics, has been a member of the Penn Dental Medicine faculty since 1987. A member of The Edward H. Angle Society of Orthodontists since 2003, he has been active in The American Board of Orthodontics throughout his career, serving as President in 2017-2018, as Director from 2010-2018, and as an ongoing consultant to the Board. Dr. Chung is also active in The American Association of Orthodontists; he served as the Co-chair of the Scientific Program of the Annual Session of the American Association of Orthodontists in 2018 and 2022. In addition, Dr. Chung was Associate Editor of The American Journal of Orthodontics and Dentofacial Orthopedics from 2010-2021, and since 2020, he has been on the Editorial Board of The International Journal of Oral Sciences. Since 2014, he has also served as a consultant to the Commission on Dental Accreditation.
Dr. Chung decided at the close of last year that he would be relinquishing his duties as Chairman of the Department of Orthodontics at Penn Dental Medicine once a replacement was found (he will remain a valued member of the Penn faculty thereafter); a search is currently underway for this leadership role. To honor Dr. Chung’s transformative contributions as Department Chair, the Dr. Chun-Hsi Chung Innovation & Transformation Fund has been established to support future initiatives in the Department.
To support the fund, visit > www.dental.upenn.edu/chung

JULY 28 - AUGUST 1, 2025 Penn Dental Medicine





PERIODONTICS
SELECTED PUBLICATIONS
A selection of published work (August 2024 – December 2024) by department researchers (indicated in bold).
Graves DT, Uribe SE. Advanced Imaging in Dental Research: From Gene Mapping to AI Global Data Journal of Dental Research. 2024. doi: 10.1177/00220345241293040.
Sahingur SE, Culshaw S, Zhang P. Regulation of metabolism and inflammation: Links with oral and systemic health: Part 3—Emerging concepts from pathogenesis to therapy. Molecular Oral Microbiology 2024;39(4):153-5. doi: 10.1111/ omi.12476.
PREVENTIVE & RESTORATIVE SCIENCE
NEWS/ACHIEVEMENTS
Dr. Alina O’Brien, Division of Pediatrics, received the Samuel D. Harris Research and Policy Fellowship from the American Academy of Pediatric Dentistry.
Dr. David Hershkowitz was promoted to Associate Chair of the Department of Preventive & Restorative Sciences.
Selected Publications
A selection of published work (August 2024 – December 2024) by department researchers (indicated in bold).
Ayub JM, Santos T, Figueredo M, Conejo J, Blatz MB. Print/Press Workflow With a Novel Silicate Ceramic Material: A Case Report. Compend Contin Educ Dent. 2024;45(10):508-12.
Eggmann F, Blatz MB. Recent Advances in Intraoral Scanners. Journal of Dental Research. 2024. doi: 10.1177/00220345241271937.
Eggmann F, Blatz MB. The Core of Digital Dentistry: Intraoral Scanners. Compend Contin Educ Dent 2024;45(10):503-7. PubMed PMID: 39561342.
Glick M. Embracing the need for a Whole Health Home. Journal of the American Dental Association. 2024;155(11):907-9. doi: 10.1016/j. adaj.2024.02.003.
Puri N, Atria PJ, Oquendo A, Blatz MB, Sampaio CS. A fully digital workflow involving 3D printed tooth reduction guides and injection resin-indexes to restore an impacted canine. Journal of Esthetic and Restorative Dentistry. 2024;36(10):1388-95. doi: 10.1111/ jerd.13273.
Rivera M, Blatz MB. A New Era for Indirect Restorations With CAD/CAM and 3D Printing Technologies. Compend Contin Educ Dent. 2024;45(10):526-7. PubMed PMID: 39561346.
Bashary N, Brewster J, Gill P, Janal MN, Özcan M, Husain NAH, Zhang Y Long-Term Bonding Efficacy of CAD/ CAM Hybrid Restorative Materials and Universal Adhesives. European Journal of Prosthodontics and Restorative Dentistry. 2024;32(3):270-6. doi: 10.1922/ EJPRD_2455Bashary07.
Çeliksöz O, Tepe H, Yaman BC, Dikmen Z, Ozer F. The effect of a universal cleaning agent on the bonding performance of a self-adhesive cement to contaminated dentin surfaces. American Journal of Dentistry 2024;37(5):230-6.
Conejo J, Han S, Atria PJ, Stone-Hirsh L, Dubin J, Blatz MB. Full digital workflow to resolve angled adjacent dental implants: A dental technique. Journal of Prosthetic Dentistry. 2024;132(2):306-9. doi: 10.1016/j.prosdent.2022.07.012.
Conejo J, Sanchez-Lara A, Rivet C, LaMar F. Digital Workflow for a Definitive Implant-Supported Hybrid Prosthesis. Compend Contin Educ Dent 2024;45(10):520-4. PubMed PMID: 39561345.
Crins LAMJ, Opdam NJM, Huysmans MCDNJM, Zhang Y, Loomans BAC. An in vitro evaluation of the fatigue behavior of resin composite materials as part of a translational research cycle. Dental Materials. 2024;40(9):1409-16. doi: 10.1016/j.dental.2024.06.010.
D’Alessandro C, Josic U, Mazzitelli C, Maravic T, Graham L (Co-Author in Leon Levy Dental Medicine Library), Barausse C, Mazzoni A, Breschi L, Blatz MB. Is zirconia surface etching a viable alternative to airborne particle abrasion? A systematic review and meta-analysis of in vitro studies. Journal of Dentistry. 2024;151. doi: 10.1016/j. jdent.2024.105394.
Hao J, Chen C, Pavelic K, Ozer F. ZIF-8 as a pH-Responsive Nanoplatform for 5-Fluorouracil Delivery in the Chemotherapy of Oral Squamous Cell Carcinoma. International Journal of Molecular Sciences. 2024;25(17). doi: 10.3390/ijms25179292.
Kim YK, Conejo J, Wagner DJ, Britton E, Schoenbaum TR. Contemporary Rationales for Cemented Implant Restorations in the Esthetic Zone. Journal of Esthetic and Restorative Dentistry 2024. doi: 10.1111/jerd.13330.
Labarca TF, Ortuño D, Neira L, Andrade G, Bravo FJ, Cantarutti CR, Dallaserra M, Gatarayiha A, Karajgikar J, Kulchar RJ, Liu X, Martins-Pfeifer CC, Olivares N, Pilcher L, Pahlke S, Pirela C, Sanchez JM, Song A, Urquhart O, Vargas JP, Véliz C, Verdugo-Paiva F, Vergara P, Zaffiri V, Zuñiga J, Makino Y, Glick M, Carrasco-Labra A. Oral Health Research in the WHO African Region between 2011 and 2022: A Scoping Review. Journal of Dental Research. 2024. doi: 10.1177/00220345241272024.
Lewis SR, Riley P, Deligianni E, Glenny AM, Glick M, O’Malley L, et al. Interventions for preventing oral mucositis in people receiving cancer treatment: photobiomodulation. Cochrane Database Syst Rev. 2024;12(12):Cd016068. Epub 20241203. doi: 10.1002/14651858.Cd016068.
Madeira L, Weber KR, Carpenedo N, Zhang Y, Porto TS, Meira JBC, et al. Effect of elastic gradients on the fracture resistance of tri-layer restorative systems. Dental Materials. 2024;40(11):1862-71. doi: 10.1016/j. dental.2024.08.004.
Rivera M, Blatz MB. The Evolution of Adhesives Leads to Current Innovations. Compend Contin Educ Dent. 2024;45(9):472-4. PubMed PMID: 39561339.
Rivera M, Blatz MB. Leveraging Digital Smile Design Technology in Esthetic Restorative Dentistry. Compend Contin Educ Dent. 2024;45(10):498-502. PubMed PMID: 39561341.
Ryu JH, Mangal U, Kwon JS, Seo JY, Byun SY, Lee YH, Jang S, Hwang G, et al. Integrating Phosphate Enhances Biomineralization Effect of Methacrylate Cement in Vital Pulp Treatment with Improved Human Dental Pulp Stem Cells Stimulation. Advanced Healthcare Materials. 2024. doi: 10.1002/ adhm.202402397.
Saleh O, Spies BC, Brandenburg LS, Metzger MC, Lüchtenborg J, Blatz MB, et al. Feasibility of using two generative AI models for teeth reconstruction. Journal of Dentistry. 2024;151. doi: 10.1016/j.jdent.2024.105410.
Shrestha R, Reddy N, Fredeen S, Zhang Y, Kim J. Functionally graded bi-material interface for Porcelain Veneered Zirconia dental crowns: A study using viscoelastic finite element analysis. Dental Materials. 2024;40(8):1267-81. doi: 10.1016/j.dental.2024.06.007.
Urquhart O. New ADA clinical practice guideline for pharmacological management of acute dental pain in children. Pediatr Dent. 2024;46(5):331. PubMed PMID: 39420487.
Verdugo-Paiva F, Urquhart O, Matanhire-Zihanzu CN, Martins-Pfeifer CC, Booth E, Booth HA, Aljarahi H, Button J, Pinto-Grunfeld C, Villanueva J, Kohler IV, Glick M, Carrasco-Labra A. Barriers to and facilitators for creating, disseminating, implementing, monitoring and evaluating oral health policies in the WHO African region: A scoping review. Community Dentistry and Oral Epidemiology. 2024;52(6):775-85. doi: 10.1111/cdoe.12984.

“We’re creating more opportunities for our students within Penn Dental Medicine, throughout the University, and beyond our campus.”
— DR. SINEM ESRA SAHINGUR
In the last four years, Penn Dental Medicine has launched three innovative master’s degree programs: the Master of Oral Health Science (MOHS), the Master of Advanced Dental Studies (MADS) and the Master of Science in Oral and Population Health (MOPH). These new programs join the more established Master of Science in Oral Biology (MSOB) and Doctor of Science in Dentistry (DScD) to offer students a total of five advanced graduate degree programs to enhance their knowledge and research skills across dental and health-science related fields — three of which provide dual-degree options for Penn Dental Medicine students.
“These new programs are quite pioneering,” says Dr. Sinem Esra Sahingur, Associate Dean for Graduate Studies and Student Research. When she joined Penn Dental Medicine in fall 2019, one of her top priorities was to help develop new master’s degree programs that would expand the School’s educational opportunities.
“MADS is our first hybrid program and is unique among dental schools,” Sahingur says of the mostly online program with an in-person clinical component. In addition, the MOPH program, which enrolled its first class in fall 2023, is a fully online program with no geographic boundaries.
The successful development and launch of these programs were partly driven by the COVID-19 pandemic, which significantly disrupted global operations in early 2020 and changed attitudes about the viability
and value of online courses, Sahingur says. This shift in perspective opened the door to new ways to deliver educational programs that don’t require students to be on campus all the time.
“We’re creating more opportunities for our students within Penn Dental Medicine, throughout the University, and beyond our campus,” she notes.
One of the overarching goals of developing new graduate degree opportunities and adding dual-degree options for both predoctoral and postgraduate students is to provide them with the knowledge and skills to pursue academic careers, Sahingur notes.
At the same time, the online and hybrid programs offer flexibility for those who want to continue their education but can’t step away from their jobs or lives for a significant period of time. “Our online and hybrid
programs provide an opportunity for those who don’t have the ability to come here in person for a year or more,” Sahingur says. “They also allow Penn Dental Medicine to be more engaged globally.”
Following is a look at Penn Dental Medicine’s Advanced Graduate Degree Programs and some of the students enrolled in them.
OPPOSITE: Dr. Esra Sahingur, Associate Dean for Graduate Studies and Student Research with the current Master of Oral Health Sciences students (left to right) Speline Irakoze (GD’25), Rashid Ajarmeh (GD’25), Zoe Belen Brown (GD’25), Eva Li (GD’25), and Yahia Abuhasan (GD’25).
When Christopher Oshana (D’27, GD’27) started dental school last year, he already had a strong interest in working with underserved populations. As a National Health Service Corps scholar, he is committed to serving three years with the Corps after graduation.
Underscoring that interest, this semester Oshana joined the second cohort of predoctoral students enrolled in the Master of Science in Oral and Population Health (MOPH) program, which was offered as a dual-degree option for DMD students when the program launched in the 2023–2024 academic year. Currently, eight students are enrolled in this two-year, fully on-line program, with seven pursuing MOPH as a dual degree alongside their DMD studies.
The MOPH is designed to respond to a critical need for public and population health leaders who can inform, develop, implement and evaluate policies that address challenges in oral health, from the local to the global level.
For Oshana, enrolling in the program was a logical choice. “The MOPH provides another opportunity to prepare for a career serving populations with oral health needs that are often unmet,” he says. “The MOPH degree will allow me to possibly enter a career in academia or public health policy and train me as a future agent of change in dentistry.”
In January, Oshana was named the first recipient of a new CareQuest Institute Scholarship designated for a student in the MOPH program. The scholarship, which awards $45,000 annually for two years, is sponsored by the CareQuest Institute for Oral Health.
“The MOPH provides another opportunity to prepare for a career serving populations with oral health needs that are often unmet. It will allow me to possibly enter a career in academia or public health policy and train me as a future agent of change in dentistry.”
— CHRISTOPHER OSHANA

The two-year, online MOPH program incorporates both recorded lectures, which students can watch on demand, and realtime class discussions via video conferencing. This format allows students to learn from oral and population health leaders from all over the world.
Once in the program, which is housed in Penn Dental Medicine’s Center for Integrative Global Oral Health, MOPH students choose a focus area in either oral and population health research; health services research, management and policy in oral health; or community and population-based oral health promotion.
This semester, Oshana has been taking foundational MOPH courses in epidemiology, population and public health, and ethics, and can already envision how the program may impact his career. “In my service years, I’ll be working with underserved populations,” he says, “and I want to treat them with empathy and respect while providing the best possible care.”
ABOVE: Christopher Oshana (D’27, GD’27) is pursuing a Master of Science in Oral and Population Health (MOPH). He was named the first recipient of a new CareQuest Institute Scholarship designated for a student in the MOPH program.
OPPOSITE: Dr. Kristen Richey (GD’25), a third-year periodontics resident, enrolled in the MSOB program because she wanted to do more in-depth research and learn to evaluate published studies more critically.
This academic year, 40 of Penn Dental Medicine’s 145 postgraduate students in specialty programs are also enrolled in the Master of Science in Oral Biology program. This dual-degree option has long been popular for students who want to integrate more extensive research or evidence-based learning into their specialty training, particularly for those interested in pursuing academic and research-focused careers.
Now, the MSOB program will soon be expanding to include two new groups of students. In the 2025–26 academic year, the MSOB will be offered as a new dualdegree option for predoctoral students, and the following year, the program will open to qualified applicants globally as a free-standing master’s program.
“We hope to inspire the next generation of clinicians, scientists, and leaders of our profession by offering our students the option to enroll in rigorous master’s degree programs,”
Sahingur says. “These programs equip students with the tools to consider academic career paths and advance their professional growth.”
Dr. Kristen Richey (GD’25), a third-year periodontics resident, enrolled in the MSOB program because she wanted to do more in-depth research and learn to evaluate published studies more critically, skills she expects to use throughout her career.
“The research experience in the MSOB as well as the coursework definitely has benefitted my knowledge and training,” says Richey, who plans to work in private practice after graduation but also expects to be involved in academia during her career. “There are so many new studies coming out about how periodontitis affects and is affected by systemic health conditions. It’s important to be able to read and interpret research papers both to understand the new knowledge in the field and be able to accurately share the information with your patients.”

“There are so many new studies coming out about how periodontitis affects and is affected by systemic health conditions. It’s important to be able to read and interpret research papers both to understand the new knowledge in the field and be able to accurately share the information with your patients.”
— DR. KRISTEN RICHEY (GD’25),
For her MSOB program, Richey has been working with Dr. Joseph Fiorellini, Director of the Graduate Dental Education Program in Periodontics and Professor of Periodontics, on a study to help determine what contributes to bone loss around dental implants. “We’re looking at a variety of factors — health patterns, types of restorations on the implant, different surgical protocols — to see if one or more may have affected the bone loss around the implant,” she says.
Richey’s main focus has been to look at how the prosthesis that covers the implant may affect bone loss, in particular
considering the angle of emergence of the restoration. “I looked at 15 different measures of the same data set,” says Richey, who will present her thesis at the end of the semester. Others on the research team are using the same implant data set to consider if other variables could lead to bone loss.
The research, Richey says, is very relevant to her specialty training. “One of the major problems in periodontics is implant bone loss,” she says, “so to try to determine some of reasons behind it is quite important.”
The Doctor of Science in Dentistry (DScD) degree gives postgraduate students the opportunity to earn a doctoral degree with a research focus along with their specialty certificates, thus preparing students for academic careers as clinical or basic science researchers. There is also a track the enables students who have completed clinical specialty training at another accredited institution to pursue a DScD alone without a certificate.
The program, which launched in 2011, has been successful in creating a pipeline for talented young scientists to pursue academic careers. At Penn Dental Medicine, there currently are seven graduates of the DScD program on the School’s full-time faculty and four who are adjunct faculty members. This academic year, 13 students are pursuing the DScD as a dual-degree option with their specialty training, and six students are enrolled solely in the DScD program.
The opportunity to pursue her specialty training in endodontics while earning a DScD degree was one of the compelling reasons Dr. Bushra Alghamdi (GD’26) came to Penn Dental Medicine.
“Being a teacher is a dream for me, and research is a very important element in my career,” says Alghamdi, a fourth-year resident who earned her dental degree at and later joined the faculty of Taibah University in Saudi Arabia. She expects to complete both her DScD and endodontics certificate program by summer 2026.
Working in the laboratory of Dr. Dana Graves, Professor of Periodontics, Vice Dean for Scholarship and Research and Director of the DScD Program, Alghamdi is investigating the impact of diabetes on periodontal disease. Her thesis is focused on the impact of hyperglycemia on the host response to bacterial-induced inflammation in periodontitis.
“Diabetes alters immune responses, increasing the risk and severity of periodontitis,” she says of the common inflammatory disease that can lead to bone loss.

“Being a teacher is a dream for me, and research is a very important element in my career. I’m very committed and inspired by what I’ve learned so far.”
— DR. BUSHRA ALGHAMDI (GD’26)
“Using single-cell RNA sequencing, we generated an atlas of diabetes-induced immune alterations and found that diabetes significantly reshapes immune cell populations, particularly in bacterial-induced periodontitis,” Alghamdi explains. “Our research highlights that diabetes amplifies inflammation by influencing neutrophil polarization and identifying γδ T cells as key players in disease progression. Notably, blocking γδ T cell activation successfully reduces disease severity, presenting a potential therapeutic target.”
The researchers are using spatial transcriptomics and the Xenium analyzer in Penn Dental Medicine’s new Spatial Transcriptomics Core to map immune reactions at the tissue level. Spatial transcriptomics maps the location of each cell in a tissue and allows researchers to measure how genes are expressed in each
cell. “This will allow us to spatially analyze diabetes-driven immune dysregulation in periodontal disease, providing deeper insights into its pathogenesis and paving the way for innovative treatment strategies to mitigate disease-related complications,” Alghamdi says.
In addition, Alghamdi is working with fellow endodontics resident Dr. Sammy Lay on another study investigating the impact of diabetes on apical periodontitis, also using spatial transcriptomics to gain deeper insights into the immune landscape of endodontic infections.
After graduating in summer 2026, Alghamdi plans to return to Saudi Arabia “with all this knowledge and a network to keep working on these issues,” she says. “Diabetes is a global problem, both geographically and in the body,” she says, “and I’m very committed and inspired by what I’ve learned so far.”
When first-year Penn Dental Medicine student Renali Patel (GD’24, D’28), graduated college with a B.S. in biology, she was interested in a dental career but felt she wasn’t quite ready to apply to dental school.
Seeking to enhance her qualifications and prepare for the application process, Patel decided to enroll in the Master of Oral Health Science (MOHS) program, one of Penn Dental Medicine’s newest advanced graduate degree programs. The one-year program provides college graduates and foreign-trained dentists with a solid foundation in oral health science, helps to demonstrate their academic potential, and provides guidance in applying to dental schools.
“I thought it was a great option to help me prepare academically for dental school and also make me a better applicant,” says Patel, who graduated from MOHS last summer and joined the first-year class at Penn Dental Medicine soon after.
The MOHS program has two tracks, including the one Patel enrolled in, which is targeted for college graduates who want to attend dental school or pursue an oral health-related career. The second MOHS track is for foreign-trained dentists who plan to apply to dental schools in the United States so they can practice in this country.
Since the first graduating class in 2022, 80 percent of the MOHS graduates have successfully matriculated into dental school programs. Currently, there are seven MOHS graduates enrolled at Penn Dental Medicine, including four students in the four-year DMD program, and three foreign-trained dentists who joined the DMD program via the two-and-half year Program for Advanced Standing Students (PASS).
The program “made me a more competitive candidate for dental school,” Patel says. In addition to research and coursework in oral health, nutrition, and immunology, she was excited to have the opportunity to shadow DMD students in the dental clinic while they worked with patients. “It was pretty cool, especially knowing I would be in that position in three years,” Patel says. “It reaffirmed my decision to become a dentist.”
“I thought it was a great option to help me prepare academically for dental school and also make me a better applicant.”
— RENALI PATEL (GD'24, D'28)
Penn Dental Medicine’s newest advanced graduate degree program, the Master of Advanced Dental Studies (MADS) that welcomed its first class in the summer 2022, offers a one-year hybrid curriculum that is primarily online, but which also includes a six-week, on-campus clinical component.
The program, for both U.S. and international dentists, allows dentists to advance their knowledge in a clinical discipline or increase their qualifications to apply to residency programs, even while continuing in their professional practice or training. Students in the program select from one of seven dental specialties.
seminars, reviewing cases, developing diagnosis and treatment plans, and observing in the clinic. In her six weeks on campus, she estimates she did more than 50 root canals on extracted teeth and was able to use the surgical operating microscope.
“It really built my skills,” Bevans says of the clinical experience.
This summer, Bevans will be moving with her family to the Philadelphia area to start her residency and is looking forward to returning to campus. In addition to the coursework and clinical experience in endodontics, the MADS program helped acclimate her to the Penn Dental Medicine community and introduced her to endodontics faculty members and residents.
“I came back feeling confident about what I had learned. It was extremely valuable clinically.”
— DR. NATASJA BEVANS (GD’24, GD’27)
It was this flexibility that made the program a compelling option for Dr. Natasja Bevans (GD’24, GD’27), who graduated in December from the MADS program with a focus on endodontics. In July, she will join the endodontics residency program at Penn Dental Medicine.
Bevans, who is in private practice in South Carolina, was able to split her on-campus clinical component into two three-week segments. “Even after the first three-week rotation, I came back feeling pretty confident about what I had learned at Penn,” she says. “It was extremely valuable clinically.”
During her on-campus component, Bevans worked and studied alongside endodontics residents, taking classes and
Although Bevans had been interested in endodontics since dental school, once she was in private practice and with a young family, she thought that moving for a yearlong general practice residency to improve her endodontics residency application was ‘not going to happen.’ The MADS program, she says, offered her an opportunity to reach her professional goals.
“It wasn’t easy, but if you love what you’re doing, it’s worth it,” she says. n
—By Debbie Goldberg
OPPOSITE: Dr. Bushra Alghamdi (GD’26) is earning a DScD along with her endodontics certificate.
The Penn Dental Medicine Alumni Society honors the accomplishments and dedication of alumni with its annual awards. This year’s awards were presented as part of Alumni Weekend 2025 at a special reception that took place May 16. The 2025 Alumni Award recipients include the following.
The Alumni Award of Merit recognizes love for and loyalty to Penn Dental Medicine, excellence in the profession of dentistry, and community involvement. The award acknowledges graduates who have maintained their ties with the School through their support of alumni activities, demonstrated leadership in the dental profession, and fostered and maintained the ideals of the School. This year’s recipients are Maria Perno Goldie (DH’71) and Dr. Nipul Tanna (D’90, GD’91, GD’10, GD’11)

Maria Perno Goldie, a 1971 dental hygiene graduate of Penn Dental Medicine, has been a leader in advancing dental hygiene and oral health overall.
A respected researcher, author, and speaker, she served as President of the International Federation of Dental Hygienists (2010-2013) and also led the American Dental Hygienists’ Association (ADHA) as President (1997–98). Goldie is a graduate of the 2004-2006 fellowship of the California Health Care Foundation’s (CHCF) Health Care Leadership Program, administered by the Center for Health Professions at the University of California, San Francisco. She is currently a member of The Oral Cancer Foundation Registered Dental Hygienist Advisory Board and part of the Editorial Advisory Board of the Journal of Dental Hygiene and the International Journal of Dental Hygiene Goldie has also served on the National Advisory Committee for the Robert Wood Johnson Foundation’s Smoking Cessation Leadership Center and the National Women’s Health Resource Center (NWHRC), Women’s Health Advisory Council. She has been recognized with the University of Pennsylvania Dental Hygiene Alumni Achievement Award (1999), the Pfizer/ADHA Award for Excellence in Dental Hygiene (2003), and the ADHA Alfred C. Fones Award from (2011), and was the first recipient of the Ann Battrell Visionary Legacy Award in 2024. She also was awarded the inaugural Distinction in Service Award from the International Federation of Dental Hygienists in 2016 and received an ADHA Presidential Citation in 2018.

NIPUL TANNA, DMD, MS
Dr. Nipul Tanna, Associate Professor of Clinical Orthodontics at Penn Dental Medicine, has been part of the Penn Dental Medicine community since earning his DMD here in 1990, after which he went on to complete an Advanced Education in General Dentistry residency (1992), the combined Orthodontics/ Periodontics program (2010), and MS in Oral Biology (2011). He joined the Penn Dental Medicine faculty in 1994, teaching as part of the Department of Preventive & Restorative Sciences through 2005 and then as part of the Department of Orthodontics (2013–present). He is a board-certified diplomate in both orthodontics and periodontics. Along with teaching at the predoctoral and postdoctoral levels, he has held numerous leadership roles, including serving as Associate Chair of the Department of Orthodontics (2022–2024), Program Director of the combined Orthodontics/Periodontics graduate dental education program (2011–present), and Clinical Co-Director, Department of Orthodontics (2020–present). He has also been a practicing orthodontics and periodontics clinician in the Penn Dental Family Practice since 2010 and was a general dental care provider in the School’s practice from 1992–2010. Among active membership in a wide variety professional and scientific societies, he is a Board Member of the Academy of Osseointegration Foundation Continuing Education Oversight Committee and a Council Member of the College of Diplomates of The American Board of Orthodontics.
The Young Alumni Award of Merit recognizes Penn Dental Medicine alumni one to 15 years from graduation who have maintained their ties with the School through their support of alumni activities, demonstrated leadership in the dental profession, and fostered and maintained the ideals that the School of Dental Medicine has stood for since its founding. This year’s recipients are Dr. Katherine France (D’16, GR’16, GD’18) and Dr. Roopali Kulkarni (D’19, GR’19, GD’21).
KATHERINE FRANCE, DMD, MBE

Dr. Katherine France, Assistant Professor of Oral Medicine at Penn Dental Medicine, earned her DMD at Penn Dental in 2016 along with a Masters of Bioethics. She continued on to earn her graduate dental education certificate in Oral Medicine here as well in 2018, after which she joined the School’s faculty in the Department of Oral Medicine. Since joining the faculty, she has been recognized by students with the Earle Bank Hoyt Award for Excellence in Teaching, receiving it in 2023 and 2024.
A Diplomate of the American Board of Oral Medicine, France is currently Director of the Penn Dental Medicine Oral Medicine Clinic and Co-Director of the Personalized Care/ Radiology/ Oral Medicine Honors Program. She is also a practicing clinician within the Penn Dental Family Practice and an attending in oral medicine at the Hospital of the University of Pennsylvania.
Active in Professional and Scientific Societies, France served as Reviewer (2020–2024) of the World Workshop on Oral Medicine VIII and Assistant Reviewer (2017–2019) and is currently Chair (2020–present) of the American Academy of Oral Medicine Membership Committee.
At Penn Dental Medicine, France is Vice President (2023–2025) of the Alumni Society and Chair (2023–2025) of its Nominations Committee. She is also faculty advisor (2022–present) of the Philadelphia Oral Cancer Walk and 5K, organized by Penn Dental Medicine students.
ROOPALI KULKARNI, DMD, MPH

Dr. Roopali Kulkarni, Assistant Professor of Oral Medicine at Penn Dental Medicine, is a 2019 graduate of Penn Dental Medicine, also earning a Master of Public Health. She pursued postgraduate training in oral medicine here as well, graduating in 2021, after which she joined the School’s faculty in the Department of Oral Medicine. She currently serves as the Assistant Director (2022–present) of Penn Dental Medicine’s postgraduate oral medicine program and is on the medical staff (2021–present) in the Division of Oral Medicine at Penn Medicine. Since joining, she received the Earle Bank Hoyt award for dedication and excellence in teaching in 2022.
Kulkarni is widely engaged in scholarly activity and organized dentistry at the local, state, and national levels. Among many different roles, she is currently serving as an Assistant Reviewer (2023–present) in the World Workshop on Oral Medicine IX, national media spokesperson (2021–present) of the American Dental Association, ChairElect (2025–present) of the Oral Diagnosis and Oral Medicine Section and Memberat-Large (2025–present) of the Council of Faculties of the American Dental Education Association, and President-Elect (2025–present) of the Philadelphia County Dental Society. She was also a 2024 American Dental Association “10 Under 10” award recipient.
The honorary alumni awards are presented to individuals who are not graduates of Penn Dental Medicine but have demonstrated a strong commitment to Penn Dental Medicine through their service to and involvement with the School. This year’s recipient is Susan Schwartz, Director of Career Services.

Susan Scwartz, Director of Career Services, has spent her entire career and graduate school (earning her MSEd in 1975) at the University of Pennsylvania, pursuing her interest in higher education. She worked in undergraduate admissions and at the School of Nursing as Associate Director of Admissions and Student Affairs before joining Penn Dental Medicine in 2000 as Assistant Dean for Student Affairs. At the same time (2006-2014), Schwartz was engaged with undergraduate students as Associate Faculty Director in Fisher Hassenfeld College House at Penn, a shared role with her husband, Dr. Sandy Schwartz, who was the Director. She served as Assistant Dean for Student Affairs until spring 2019 when she moved into her current position, establishing a Career Services Division in the Student Affairs Office. The objective of the Division is to help students explore and plan for next steps after dental school as well as long-term professional goals. Services include career advising, CV and personal statement review, mock interviews, and a variety of professional development programming. Among key programs of the Division is a six-part Selective series utilizing the wisdom and experience of dental alumni, and a two-day Career Fair with private, federal, and community-based dental practices, GPR and AEGD programs, and representation from all postgraduate programs at Penn Dental Medicine. Schwartz also works with the continued…
(continued)
School’s Office of Institutional Advancement to help students connect with Penn Dental Medicine alumni for mentoring and shadowing opportunities. Schwartz notes that the resources of the Career Services Division are
available to alumni at any point in their dental careers. She was also recognized with honorary membership in the Penn Dental Medicine OKU ETA Chapter in 2010.
The Charlotte J. Sullivan Lifetime Achievement Award, established by the Alumni Society Executive Board in 2024 and previously given by the Penn Dental Hygiene Alumni Association, recognizes Penn Dental Medicine dental hygiene graduates for extraordinarily meritorious contributions advancing the dental hygiene discipline. The award is named in honor of the inaugural director of Penn Dental Medicine’s Oral Hygiene program, founded in 1921. The award is conferred only when the Board feels there is a dental hygienist who should be so honored. This year’s recipient is Lisa Solden Schildhorn (DH’75).

Lisa Solden Schildhorn, a 1975 dental hygiene graduate of Penn Dental Medicine, has worked with various professional and community organizations to enhance and advocate for oral health as an essential part of general health. Her many professional roles throughout her 50-year career have included clinician, educator, practice manager, business owner, entrepreneur, organizational development consultant, and community health advocate. After practicing clinically, teaching Penn dental hygiene students, and managing one of the School’s practices, Schildhorn took the leap as an entrepreneur in 1981, establishing Dental Power of Delaware Valley, Inc. Over 21 years, she expanded Dental Power into a premier dental search firm in Philadelphia and the surrounding counties, assisting dental professionals in obtaining temporary and direct-hire employment. After transitioning Dental Power to new leadership in 2002, Schildhorn began her consulting firm, LLC Dental Team Consultants, working with various organizations on educational programs and workshops, leadership training, grant writing, coalition capacity building, and stakeholder engagement. As part of her consulting activities, she worked with the team to establish and build capacity for the Pennsylvania Coalition for Oral Health, serving on the Board of Directors for 10 years. Schildhorn’s non-profit activities include having served on the Board of Directors of Living Beyond Breast Cancer, Susan G Komen Race for the Cure, Heath Federation Early Head Start, and Kids Smiles, where she was President from 2005 to 2009.
When interviewed for RDH magazine in 2013 and asked for her advice to others, she said, “Believe in your strengths. Find the parts you love to do, and that creates the energy you need to succeed in life. I’m just doing what I love.”


The Hong Kong-based clinical practice of Dr. William Cheung (D’81, GD’82) has evolved through five-generations of Penn Dental Medicine alumni. The journey began with Dr. Chaun Moon Hung, who, at 13, traveled from Guangdong Province to Philadelphia, becoming the first Chinese heritage student at the University of Pennsylvania School of Dentistry, graduating in 1899. He returned to Hong Kong in 1901, establishing a successful practice.
His son, Dr. Kenneth Kwok Wing Chaun, continued the Penn Dental Medicine legacy, joining the practice after graduating from Penn in 1925. He invited his nephew, Dr. Philip Po Cheung Chan, a 1955 Penn Dental Medicine graduate, to the practice, and Dr. Chan welcomed Dr. William Cheung to their team soon after he graduated from Penn Dental Medicine in 1981. In 1994, Dr. Cheung took over the practice, gradually expanding it to include various specialists. Dr. Cheung’s vision was to provide a place where a patient’s oral health needs could be managed all under one roof. His daughter, Dr. Stefani Li Lin Cheung, a 2011 Penn Dental Medicine graduate, joined the practice in 2014. In 2020, the practice welcomed Dr. Steven Koon Ming Poon, who completed specialty training in Periodontics and Prosthodontics, along with a Master’s degree, at Penn Dental Medicine.
This marks over 120 years of practice by Penn Dental Medicine alumni, proudly upholding the Penn Dental Medicine legacy of emphasizing comprehensive and preventive oral healthcare.
Susan Lentz Kass (DH ’75) has been proud to represent her fellow dental hygienists as Chair of the American Dental Education Association.
A longtime director of the dental hygiene program at Miami Dade College, Susan Lentz Kass, (DH’75, MEd, EdD) has been actively involved with the American Dental Education Association (ADEA) for many years. She served as a mentor for the ADEA’s Allied Leadership Development Program and later sat on the Board of Directors. In 2016, she received a Chair of the ADEA Board Citation in recognition of exceptional service to the Association and the dental education community.
Still, she never considered that she would be elected Chair of the national organization, which works to further the education of dental professionals and advance academic dental programs in the U.S. and Canada.
One day in 2022, Susan recalls, she received a phone call from a colleague. “She said, ‘Susan, I’m calling about the Chair of the ADEA board.’ I said, ‘Let me think of some recommendations.’ And she said, ‘What are you talking about? I’m calling to see if you will run!’ It had never crossed my mind.”
Her response was perhaps unsurprising considering that in its 101-year history, the ADEA has had only two other Chairs who were dental hygienists. When Susan was elected in 2023, she became the first dental hygienist not affiliated with a dental school to hold the position. “That’s the really special part of this,” she says. “It’s about what I represent to this population, for them to see that somebody who is an allied dental professional is qualified for this role.”
The ADEA has always been inclusive of dental professionals who are not dentists, says Susan, though much of the programming historically has been geared toward dental educators and dental students. The Allied Leadership Development Program that she has proudly advised and been a mentor for since its launch in 2003, was emblematic of an invigorated focus on educators in dental assisting, dental hygiene, dental laboratory technology, and dental therapy. For the delegates to vote her in as Chair of the organization, she says, “really showcased their embracing of the allieds.”


“It’s such a powerful experience to serve populations that get minimal dental care and to be able to bring that experience to our students.”
— SUSAN LENTZ KASS
Holding the position of Chair at the ADEA is a three-year commitment, with a year as Chair-Elect, a year as Chair — which for Susan concluded this March — and a third year as immediate Past Chair.
In her leadership role, she has worked to elevate ADEA’s voice on health-related debates, such as those pertaining to fluoridation and mercury in dental restorative materials, and to respond to legislative changes that impact dental and allied professions.
She also has worked closely with ADEA’s Envisioning and Transforming the Future of Oral Health and Education Task Force to rethink knowledge development for oral health professionals and develop a business model for a future oral health system. “We were really looking at what health education is going to look like as a whole and how dental is going to fit in,” says Susan, who has also served as a Commissioner on the American Dental Association Commission on Dental Accreditation (CODA).
Reflecting on her over four-decade career at Miami Dade College, where in addition to directing the hygiene program she has held three endowed teaching Chairs and served as Assistant to the Dean of Health Sciences, she shares that it is the student population that keeps her inspired. When students enter the dental hygiene program, Susan requests a one-on-one meeting, and she is always struck by what she learns. Many students are also parents or are working at a job while pursuing their studies or have had to start at the beginning by taking all the prerequisites before applying. “It’s remarkable what they do to get into and manage this very competitive, rigorous program,” she says. “And they succeed!”
During her time at Miami Dade, she has led several dental missions with students to Jamaica and Guyana. “That’s been a really wonderful initiative we’ve developed,” she says. “It’s such a powerful experience to serve populations that get minimal dental care and to be able to bring that experience to our students.”
Susan sees her role as an educator extending beyond academics. “I feel sometimes we forget that we’re also role models to our students,” she says, “and we need to embrace that, to be better role models, and to have the courage to not be complacent.”
In February, more than 150 students, residents, and alumni gathered at the Penn Museum for our annual Alumni-Student Networking Event.


Alumni and friends joined Dean Wolff at the Penn Club of New York to reconnect with Penn Dental Medicine during the 2024 Greater New York Dental Conference.




YANKEE DENTAL ALUMNI RECEPTION
In January, alumni and friends came together at the Yankee Dental Congress in Boston, MA.

AAP ALUMNI RECEPTION
Alumni and friends of Penn Perio came together at the American Academy of Periodontology (AAP) Annual Meeting to reconnect with Penn Dental Medicine.




Contributed by Temitayo Andrew (GD’24, D’26)
My name is Temitayo Andrew, a foreign-trained dentist from Nigeria. I graduated from the University of Ibadan in 2013 and practiced as a general dentist for nearly a decade before moving to the United States to further my education. Pursuing a Master of Oral Health Sciences (MOHS) at Penn Dental Medicine was a key step in advancing my knowledge and career. Looking back, this program has been one of the most transformative experiences of my journey. I completed the MOHS program in 2024 and am now pursuing my DMD here at Penn Dental Medicine.
My dental education at the University of Ibadan provided a strong foundation. However, years of practice exposed me to challenges in delivering optimal care, especially in resource-limited settings. I realized that enhancing my research and academic skills would enable me to make a greater impact. The MOHS program stood out for its emphasis on evidence-based learning and research, critical for improving patient care and advancing the profession.
What attracted me to the MOHS program was its research component and academic rigor. I saw it as an opportunity to refine my ability to evaluate scientific literature and apply research findings to clinical practice. Additionally, Penn Dental’s diverse and collaborative environment enriched my perspective and broadened my understanding of global dentistry.

The program exceeded my expectations. One of the most impactful aspects was the mentorship from faculty. Working on my capstone project under Dr. Yu Zhang’s guidance helped me refine my research methodology and deepen my understanding of scientific inquiry. Beyond research, faculty members challenged us to integrate evidence-based principles into clinical decision-making, strengthening my academic foundation for U.S. dental practice.
A key skill I developed in the MOHS program was critically appraising research. Through coursework and hands-on projects, I honed my ability to analyze studies and apply evidence to clinical scenarios. This has been invaluable in my current role as a dental student in the advanced standing DMD program, where research and clinical practice go hand in hand.
Direct exposure to U.S. patient care through clinical rotations and Dental Auxiliary Utilization (DAU) stood out as my favorite experience. These rotations provided firsthand insight into patient management, workflow, and
interdisciplinary collaboration to enhance productivity and patient outcomes in U.S. dentistry.
A highlight of my time in the MOHS program was presenting my capstone research at a symposium. Standing before faculty and peers, sharing my findings, and receiving feedback was rewarding. It was a defining moment that reinforced my confidence in contributing to dental research.
For prospective students considering the MOHS program, my advice is simple: embrace the challenge. The program is rigorous but rewarding. Take advantage of faculty mentorship, engage in research opportunities, and collaborate with peers. The knowledge and skills gained will prepare you for academic and professional success.
Completing the MOHS program was a pivotal step in my journey. It equipped me with critical thinking, research acumen, and the confidence to thrive in the advanced standing DMD program and beyond. More importantly, it reinforced my commitment to lifelong learning and making a meaningful impact in dentistry.

Dr. Albert Repicci (D’65), now a retired orthodontist, was honored by Columbia School of Dental Medicine (Orthodontics, ‘71) for his 35 years of foreign mission dental service in Africa, Asia, and South America, as depicted in the video “Dentistry in the Bush.” He was also recognized for his work as a foreign correspondent, reporting on the genocide trials in Cambodia, the Nazi war crime trials in Auschwitz, and the earthquakes in Nepal. Additionally, Dr. Repicci authored several stage plays that were performed off and off-off Broadway.
Dr. Arnold Weisgold (GD'65) has been honored with the Greater New York Academy of Prosthodontics 2025 Achievement Award. He currently serves as an Adjunct Professor at Penn Dental Medicine.

Dr. Joseph Hanley, Jr. (D’67, GD’69) retired from the U.S. Army as an oral surgeon and is enjoying his retirement with his wife Pat. The two are living happily in Salisbury, CT.

Dr. Ed Rossomando (D'64) was unaware of the Oral History Project at the Levy Dental Medicine Library at Penn School of Dental Medicine until recently. That all changed when he was contacted by Laurel Graham, MLS, ML, Head of the Dental Library. During a Zoom call, Laurel explained the oral history project and, to Dr. Rossomando's surprise invited him to participate. What followed was a series of zoom calls with Laurel and her colleague Rachel Canter that resulted in his oral history.

< View oral history
Dr. Joseph Greenberg (D’72, GD’76) is relishing his retirement by the beach in Boca Raton, FL. He dedicates his time to volunteering and teaching for the Alliance for Oral Health Across Borders. Dr. Greenberg also cherishes moments spent with his classmates Joel Cooper (D’72) and Bob Seltzer (D’72, GD’76), as well as his former student, Nick Cuccharale (D’82, GD’84)

Dr. Larry Erwich (D'78); Dr. Richard Lubell (D'78, GD'82); Dr. Deborah Sands Lubell (D'78); Dr. Daniel Fried (D'78); Dr. Arthur Dean (D'78); Dr. Allan Horowitz (D'78); and Dr. Andy Greenstein (C'78, D'78, GD'80), along with several spouses and friends, recently reunited in Atlantic City, NJ for a Class of 1978 class gathering.

Dr. Don Rebhun (D'80) is now in his 39th year as a faculty member at Penn Dental Medicine. Recently, he and his therapy dog, Pickles, attended the opening of the new wellness center in the Dental Library.
Dr. Edward Landau (D'71) has had an intriguing post-dentistry journey. After selling his practice to his partner in January 2020 and navigating the Covid shutdowns, he sought a more stimulating pursuit than streaming shows. Leveraging the MBA he earned years ago, he secured a position in Investment Banking. Dr. Landau is now happily working with RLS Associates in the Merger & Acquisition space, proving that retirement is anything but boring!
Shari Sparkler Karpo (DH’79) has officially retired after an impressive 45-year career, including 31 years at the same office. She is excited to begin the next chapter of her life, which will involve spending more time with her grandchildren, traveling, and enjoying the shore.
Dr. Joseph Shapira (GD’79) is living happily in Tel Aviv, Israel. He is a happily married Pediatric Dentist with three children and five grandchildren. He enjoys traveling, playing bridge and Petanque, attending theater and concerts, and teaching residents via Zoom. He also runs a prevention program for children with intellectual disabilities and works with young patients in his office.

Dr. William Cheung (D’81, GD’82) was elected to the Council of the FDI World Dental Federation at the World Dental Parliament in Istanbul last September. He has been a member of the FDI Education Committee for 18 years, including 7 years as its Chair.

Dr. Maurice Edwards (D’95), NYSDA President-Elect; Dr. Lloyd Klausner (D’87); Dr. Gail Schupak (D’83); and Dr. Egidio Farone (D’84) celebrated fellow alumnus, Dr. Michael Shreck (D’84), at the Nassau County Dental Society’s 2025 President’s Gala in January. Dr. Shreck was presented with the NCDS Herbert L. Taub Distinguished Service Award in recognition of his contributions to the Society.
Dr. Tony Saito (D’95) is excited and honored to be the White Coat Ceremony Speaker for the incoming Penn Dental Medicine Class of 2029.

Dr. Andrew Lieberman (D‘00) spent over two decades in a large, multidisciplinary practice in Delaware County, PA. He then sold his partnership share to take over and manage Main Line Snoring Solutions and Bryn Mawr Dental Arts. As a Qualified Member of the American Academy of Dental Sleep Medicine, he finds great fulfillment in managing obstructive sleep apnea through oral appliance therapy, marking an exciting new chapter in his career.
Dr. Gregg Fink (D’02) founded the Independent Dental Society of Delaware, a non-profit organization dedicated to advocating for independently owned dental practices. Since its launch in November 2024, the society has attracted nearly 100 members. Their mission is to expand regionally and nationally, leveraging political influence to pass laws requiring dental practices to publicly disclose if they are owned by non-dentist entities.

Dr. Meeta Chawla (D’15) says it’s incredible how quickly the last 10 years have gone by. After completing dental school, Dr. Chawla began practicing dentistry and embraced all its challenges. However, after a few years, she discovered her true calling in education. She is thrilled to share that she is now an Assistant Professor in the Department of Preventive and Restorative Sciences at Penn Dental Medicine. Dr. Chawla considers it a privilege to pay it forward and inspire the next generation of dentists. She looks forward to reconnecting and hearing about everyone's journeys.
Dr. Sharon Aradine (D’16) recently secured a book publishing deal for her personal diaries. In this book, she shares her journey of battling and overcoming mental health crises, publishing it under her own name.
Dr. Evanthia Anadioti (D’17) and Dr. Ana Kodra (D’19, GD’24) were both recently elected as governors from the Philadelphia County Dental Society.

Dr. Roopali Kulkarni (D’19, GR’19, GD’21, RES’21) was installed as the President Elect of the Philadelphia County Dental Society.
Dr. Christopher Lai (C’13, NU’13, D’19) recently received the 2024 President's Recognition Award for Outstanding Service from the Philadelphia County Dental Society.

Dr. Grace Huang (C'18, D'21) married Tommy Pan Fang (ENG'15, W'15, GEN'16) in Playa del Carmen, Mexico. Her bridesmaids included Penn Dental Medicine alumnae Dr. Sepideh Noorani (D'21, GD'24), Dr. Hillary Liu (D'21), and Dr. Sherry Yang (GD'24). She is now a Clinical Assistant Professor and serves as the Predoctoral Orthodontics Program Director at the University of Texas Health Science Center at Houston, School of Dentistry. She also practices part-time in Houston.
Dr. Kylie Schlesinger (D’22) has launched a new podcast titled “Medical Morons” alongside her father. In each episode, they chat with successful practice owners from diverse fields to reveal the keys to running a thriving practice. Check it out on Spotify!

Dr. Reem Ibrahim (D’24) chose Penn Dental Medicine for its Personalized Care Unit, inspired by her sister's battle with Multiple Sclerosis and the struggle to find suitable dental care. This experience fueled her dedication to special needs dentistry. Now practicing in San Diego, CA, Dr. Ibrahim welcomes patients of all abilities and extends her gratitude to the professionals at the Personalized Care Unit for their support.
“It is a true privilege to provide care for patients in need,” she says.
you can send your submissions to:
Schattner Center Penn Dental Medicine Office of Institutional Advancement 240 South 40th Street Philadelphia, PA 19104

Robert P. Gibson (D’43)
Maplewood, MN, September 24, 2024
Morton R. Brenner (D’46) Worthington, MA; December 1, 2024
Frances Skorol Zikaras (DH’46) Hamden, CT; December 27, 2024
Jay D. Edwards (C’49, D’51) Vero Beach, FL; October 10, 2024
Robert J. Sutton (D’49, D’52) Lansdale, PA; November 3. 2024
Rose Mary Flood Fitzpatrick (DH’54) Drexel Hill, PA; February 17, 2025
Ralph G. Frick (GD’55) Largo, FL; November 12, 2024
Bernard M. Mechlowitz (D’56) Toms River, NJ; October 24, 2024
Elizabeth Samson Puffer (DH’56) Plymouth, MA; March 27, 2024
William R. Shoulberg (C’53, D’56) Scottsdale, AZ; September 30, 2024
Dewey B. Pavlock (D’57) New Oxford, PA; March 26, 2025
Murray Stein (GD’57) Shaker Heights, OH; December 2, 2023
Thomas G. Woodman (D’57) Auburn, ME; October 14, 2024
Loretta David Brubaker (DH’56) Wynnewood, PA; March 8, 2025
Daniel F. Sazima (GD’58) Chagrin Falls, OH; March 22, 2025
Barry Benn (D’60) San Diego, CA; October 21, 2024
Carole Kurtz Hewitt (DH’60) Chester Springs, PA; October 20, 2024
Harvey Wenick (D’60) Alexandria, VA; September 17, 2024
Nicholas T. Hallick (GD’61)
Corpus Christi, TX; March 8, 2025
Sidney N. Millstein (D’61)
Miami, FL; January 9, 2025

In the fall of 2023, beloved Penn Dental Medicine teacher, mentor, and friend Dr. Nathan Kobrin passed away. A clinical assistant professor of restorative dentistry from 1993 to 2020, he was a mentor for his students and leader among his colleagues in the preclinical laboratories at the School. To preserve his legacy, fundraising efforts are underway to name a window in the preclinical lab in his memory. Support this lasting legacy at www.dental.upenn.edu/annualgiving (When making a gift, note "Dr. Kobrin" in the memorial section)
Jack W. Falsion (D’62)
Brockport, NY; January 27, 2025
Howard Berg (C’59, D’63) San Jose, CA; October 18, 2024
James C. Clayton (D’63) Venice, FL; November 28, 2024
Geoffrey M. Drawbridge (D’63) Naugatuck, CT; December 3, 2024
Vincent A. Parisi (D’64, GD’65) Reading, PA; January 23, 2025
Kathleen Ann Lewis (DH’65) Hershey, PA; February 20, 2025
Peter L. Manis (D’65, GD’69) Haverhill, MA; June 18, 2024
Stanley M. Baer (D’66) Morristown, NJ; March 14, 2025
Kenneth H. Rosenfield (D’66) Sarasota, FL; December 1, 2023
Alexander W. Hochheiser (C’64, D’67) Vero Beach, FL; October 27, 2024
Kenneth M. Pearson (D’70) East Montpelier, VT; January 13, 2025
Gary Berchenko (D’71) Shokan, NY; January 12, 2025
Captain Paul Robert Moore (D’71) Jacksonville, FL; February 11, 2025
Pamela Kresge Kassner (DH’72) Harrisburg, PA; October 9, 2024
Neal B. Forbes (D’74) Mentor, OH; February 25, 2024
Dobroslav M. Valik (D’75) Piešťany, Slovakia; August 8, 2024
Ronald L. Rupp (D’76) Califon, NJ; March 20, 2024
Rebecca A. Weber (D’77) Riva, MD; March 26, 2025
Madeline S. Ginzburg (D’79, GD’80) Riverdale, NY; December 7, 2024
Philip H. Ehret (D’80) Manchester, VT; February 10, 2025
Jeffrey L. Rubin (C’77, D’81, GD’82) Asheville, NC; December 8, 2024
Anna C. Giacalone (D’82) Virginia Beach, VA; January 17, 2025
Christopher V. Hughes (D’82) Ocean Isle Beach, NC; February 25, 2025
Robert S. Gurmankin (D’84) Philadelphia, PA; August 2 ,2024
Dominique St Juste (D’95) Brooklyn, NY; May 4, 2024
MAY 13
Senior Farewell
The Bellevue, Philadelphia
MAY 15
Advances in Clinical Care & Education (ACCE) Day
Penn Dental Medicine
MAY 15
American Academy of Oral Medicine (AAOM) Reception
Las Vegas
MAY 16–17
Alumni Weekend
Penn Dental Medicine
MAY 19
Commencement
Irvine Auditorium
University of Pennsylvania
MAY 29
CDE: 2025 Center for Innovation & Precision Dentistry (CiPD) Symposium
Penn Dental Medicine
JUNE 3
CDE: Endodontics Class of 2025
Final Case Presentations
Penn Dental Medicine
JUNE 16
CDE: Penn Pediatrics Virtual
Study Club ft. Dr. Jennifer Clark
Live Webinar
JUNE 18
CDE: Persons with Disabilities
Presentation Series ft. Dr. Corrie Crowe
Live Webinar
JUNE 18
CDE: Wellness from Within ft. Dr. Bill Claytor, Jr.
Live Webinar
JULY 28–AUGUST 1
CDE: 7th Penn Periodontal Conference Penn Dental Medicine
AUGUST 12
White Coat Ceremony
University of Pennsylvania
SEPTEMBER 12
CDE: Towards Unity for Health 2025
Penn Dental Medicine
SEPTEMBER 18
American Association of Oral and Maxillofacial Surgeons (AAOMS) Reception
Washington, DC
SEPTEMBER 26–28
CDE: Bender Seltzer Grossman Academic Review of Endodontology
Penn Dental Medicine
OCTOBER 3–4
CDE: Penn International Symposium on Digital and Implant Dentistry
Penn Dental Medicine
OCTOBER 17
American Academy of Periodontology (AAP) Reception
Toronto
OCTOBER 23
American College of Prosthodontists (ACP) Reception
NOVEMBER 7–8
CDE: Penn Periodontics & Periodontal-Prosthesis: The Evolution of a Paradigm
Penn Dental Medicine
NOVEMBER 14–15
CDE: Penn Interdisciplinary Microscopy Symposium
Penn Dental Medicine
DECEMBER 1
Greater NY Alumni Reception
New York
DECEMBER 5
Ortho Alumni Day
Penn Dental Medicine
Visit www.dental.upenn.edu/events or call 215-898-8951 for information on alumni events

New Orleans Visit
www.dental.upenn.edu/cde or call 215-573-6841 for information on continuing dental education programs

PENN DENTAL MEDICINE ALUMNI SOCIETY
2024–2025 EXECUTIVE COMMITTEE
Alyssa Greenberger, D‘02 President
Katherine France, D‘16, GR‘16, GD‘18
Vice-President
Members-at-Large
Pam Alberto, D‘80
David Boschken, D‘98, GD‘00
Scott Chanin, D‘83
Travis Chirman, D‘24
Gail Spiegel Cohen, C‘76 D‘80
Milan Doshi, D‘07
Keith Dunoff, D‘84
Caryn Siegel Finley, C‘95 D‘99
Kara Fraiman, D‘92, GD‘94
Andrew Fraser, D‘16
Maria Perno Goldie, DH‘71
Andrew Henry, D‘12 M‘15 GD‘18
Stephen Howarth, D‘16
Ken Ingber, D‘71
Donna Jankiewicz, D‘88
Ana Kodra, D‘19, GD‘24
JV Kracke, D‘17 GD‘19
Daniel Kubikian, D‘01 GD‘04 GD‘05
Roopali Kulkarni, D‘19 GR‘19 GD‘21
Bernard Kurek, D‘73 WMP‘03
Kristen Leong, C‘16 GED‘20 D‘21
Bret Lesavoy, D‘19
Kevin Luan GD‘17
Craig McKenzie, GED‘20, D‘21
John Newland D‘84
Ngozi Okoh, D‘12
Nimesh Patel, D‘09
Lindsay Pfeffer, D‘08 GR‘08
Shabnam Sedaghat, D‘06
Josh Simpson, D‘16
Matt Sones, D‘12
Ann Eshenaur Spolarich, DH‘82
Shari Summers D‘83
Ben Truong, D‘19
Michael Yasner, C‘79 D‘83 GD‘84 GD‘86
Sarah Yoon D‘07, GD‘13
Brigitte White Zinkovic, CGS‘04 D‘07
David Tai-Man Shen, DMD, D’79, GD’81, Chair
Stanley M. Bergman - Emeritus
Dirk Brunner, MSC, MBA
Julie Charlestein
William W. M. Cheung, DMD, D’81, GD’82 - Emeritus
Joanne Chouinard-Luth, DMD, D’79
Terri Dolan, DDS, MPH
Matthew J. Doyle, PhD
Egidio Farone, DMD, D‘84
Allen Finkelstein, DDS
Ruchi Goel, WG’04
David Kochman
Myechia Minter-Jordan, MD
Anne Koch, DMD, D’77, GD’93
Vincent Mosimann
Catherine O’Hern Lyons, MBA, C’86
Joan O’Shea, MD
Daniel W. Perkins
Garry Rayant, DDS, GD’77
Maria Ryan, DDS, PhD
Tony Saito, DMD, D’95
Thomas Schweiterman, MD
Alfred L. Spencer, Jr.
Heather Trombley
Joerg Vogel
Robert Zou, WG’94
Ex Officio Members
Martin D. Levin, DMD, D’72, GD’74, Chair, Dean’s
Council Alyssa Greenberger, DMD, D’02, President, Alumni Society
DEAN’S COUNCIL
Martin D. Levin, D’72, GD’74, Chair
Gail E. Schupak, D’83, Vice Chair
Robert Brody, C’80, D’84
Stefani Cheung, C’08, D’11
Charlene Jennings Fenster, DH’75
Joseph P. Fiorellini, DMD, DMSc
Howard P. Fraiman, D’91, GD’93, GD’94
Joseph E. Gian-Grasso, C’67, D’71
C. Mitchell Goldman
Jeffrey N. Grove, D’04
Elliot Hersh, DMD, MS, PhD
Anil J. Idiculla, C’98, GD’06
Christopher Joy, D’80
Meetu Kohli, D’02, GD’05
Brian Lee, D’00, GD’04
Richard Levitt, C’68, D’72, GD’77
Daniell J. Mishaan, D’03
Saul M. Pressner, D’79
Michael Ragan, D’77
Daniel Richardson, D’02
Louis Rossman, D’75, GD’77
Derek Sanders, D’06
Trina Sengupta, D‘08
Tara Sexton, D’88
Robert Stern, D’87
Susan Stern, C’77, D’81
Arnold Weisgold, GD’65
Beth Adams
Director of Publications
Dr. Faizan Alawi
Associate Professor, Basic & Translational Sciences
Associate Dean for Academic Affairs
Dr. Markus Blatz
Professor of Restorative Dentistry
Chair, Department of Preventive & Restorative Sciences
Sarah Burton Flynn
Director of Strategic Development & Alumni Relations
Maren Gaughan
Associate Dean for Leadership Giving
Dr. Joan Gluch
Division Chief and Professor of Clinical Community
Oral Health, Associate Dean for Academic Policies
Dr. Dana Graves
Professor, Department of Periodontics
Vice Dean for Research and Scholarship
Elizabeth Ketterlinus
Vice Dean of Institutional Advancement
Dr. Robert Ricciardi
Professor, Acting Chair, Department of Basic & Translational Sciences
Dr. Thomas Sollecito
Professor of Oral Medicine
Chair, Department of Oral Medicine
Margaret Yang
Director of Student Affairs and Engagement
INSTITUTIONAL ADVANCEMENT
Elizabeth Ketterlinus, ekett@upenn.edu
Vice Dean of Institutional Advancement
Maren Gaughan, gaughan@upenn.edu
Associate Dean for Leadership Giving
Sarah Burton Flynn, sburton@upenn.edu
Director of Strategic Development & Alumni Relations
Lindsay Murphy, lhonzak@upenn.edu
Associate Director of Annual Giving
Matthew Breen, breen1@upenn.edu
Assistant Director of Events Services
Domenic Gaeta, dtgaeta@upenn.edu
Development Coordinator
Beth Adams, adamsnb@upenn.edu
Director, Publications
Pam Rice, pamrice@upenn.edu
Senior Director of Continuing Education
Rachel Dager, rdager@upenn.edu
Associate Director of Continuing Education
Brittani Kelly, brikelly@upenn.edu
Program Coordinator of Continuing Dental Education
Office of Institutional Advancement: 215–898–8951
The University of Pennsylvania values diversity and seeks talented students, faculty and staff from diverse backgrounds. The University of Pennsylvania does not discriminate on the basis of race, color, sex, sexual orientation, gender identity, religion, creed, national or ethnic origin, citizenship status, age, disability, veteran status or any other legally protected class status in the administration of its admissions, financial aid, educational or athletic programs, or other University-administered programs or in its employment practices. Questions or complaints regarding this policy should be directed to the Executive Director of the Office of Affirmative Action and Equal Opportunity Programs, Sansom Place East, 3600 Chestnut Street, Suite 228, Philadelphia, PA 19104–6106; or (215) 898–6993 (Voice) or (215) 898–7803 (TDD).
Robert Schattner Center
University of Pennsylvania
School of Dental Medicine
240 South 40th Street
Philadelphia, PA 19104–6030

Plan a gift to Penn Dental Medicine and help shape the future of dentistry. Your commitment today fuels the innovations of tomorrow—advancing dental education, groundbreaking research, and exceptional patient care for generations to come.
There are many creative and meaningful ways to shape the future. Whether you include a gift in your will, plan a gift using retirement assets, securities, or real estate, or explore life income options like charitable gift annuities and charitable remainder trusts, your support can leave a lasting impact.
Contact us today to discover how you can leave a legacy that transforms oral health and education.
Your legacy. Their future.

